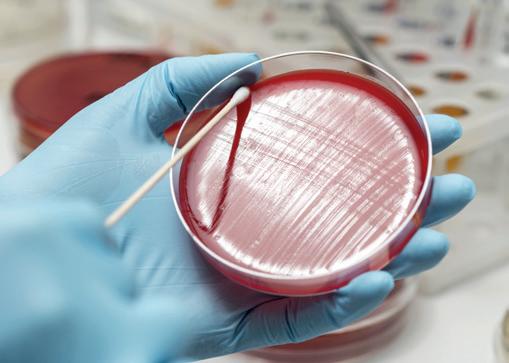

TO SUCCESS
SEXUAL HARASSMENT
Is it an issue on the racetrack backstretch?

CELEBRATING BREEDERS
Red Knight’s breeder Tom Egan on his love for horses


JERRY DIXON, JR. What’s happened to Rich Strike’s groom since the Kentucky Derby?




Is it an issue on the racetrack backstretch?

Red Knight’s breeder Tom Egan on his love for horses


JERRY DIXON, JR. What’s happened to Rich Strike’s groom since the Kentucky Derby?



Drop your foal in Virginia and earn bonuses for ANY WIN in North America, including NSA-sanctioned races. ($25,000 max on any one win) In 2021, breeders received 32% bonuses on the winning purses their VA-breds earned in North America.


Earn a 25% bonus on winning purses in the Mid-Atlantic including NSA-sanctioned meets (DE, MD, NJ, NY, PA, WV). 50% bonus on earned purses 1st – 4th at Colonial Downs. Bonuses not paid for VA-restricted races. ($10,000 max. on any one win)
Earn a 25% bonus on winning purses in the Mid-Atlantic including NSAsanctioned meets (DE, MD, NJ, NY, PA, VA, WV). Earn 10% bonus in WVrestricted races. Bonuses not paid for VA-restricted races. ($10,000 max. on any one win) To be certified, horse must complete a minimum 6-month VA residency prior to December 31 of its 2YO year. Developer is the owner of the horse in its first career start.
See VaBred.org for
or


Accelerate, Stellar Wind, Switch, Higher Power are horses whose names have helped propel our cover trainer, John Sadler, to the top echelon of the training ranks.

As Annie Lambert discovered, when she recently met with Sadler, who knew that a little boy’s encounter with horses in a field adjacent to a family’s summer vacation home would set a course toward a lifelong career with horses?
This fall and winter, the next superstar in the Sadler barn, Flightline, could further raise the proverbial bar for Sadler. Whatever he achieves on the track, will be. Period.
But this issue allows us to celebrate one of the most versatile and respected trainers, not only in the state of California but across North America.

As we discover over the coming pages, Sadler has honed his trade getting horses to perform. Whether it be in the highest profile races, in the show jumping arena—when Sadler won the Jimmy Williams High Bar class at the preOlympic horse show at Santa Anita, jumping off at 6’6” on Mr. Cove—or racing a speedy Thoroughbred against the best Quarter Horse of his time (Griswold), Sadler has proven time and time again that he is a man up for the challenge of getting the best out of the horses in his care.
Caring for horses is a lifelong passion; for many, it’s more of a vocation rather than a job. In this issue, we find out what has happened to Jerry Dixon, Jr.—Rich Strike’s groom, since the first Saturday in May.
We also discuss the subject of sexual harrasment on the backstretch: is this something that is really rife today? When does a remark, made perhaps in jest, become something which is perceived as being more sinister? Ken Snyder discovers the experiences faced by those who live and breathe horses and what avenues there are for support when it gets overwhelming.
This being our “Breeders’ Cup to Pegasus World Cup” issue, we also celebrate the importance of the “owner breeder”— those breeders who believe in their stock and race them. In the first of what I hope will become a regular feature, we profile one such breeder who purchased a broodmare, Isabel Away, at the 2003 Keeneland January sale for just $60,000.

Isabel Away has gone on to produce two stakes-winning performers in Macagone and Red Knight.
Between them, the New York-bred geldings have taken owner Tom Egan on quite a journey—winning more than $1.8 million in prize money along the way.
Egan tells us that Red Knight will be his last horse; and when his racing days are done, he is already thinking ahead to Red Knight’s second career as a hunter jumper: “He’s never going to be happy just standing out there in a field.”
Perhaps a future project for John Sadler to consider. I bet he would enjoy that challenge!
Wherever your racing takes you this winter, good luck!


Giles Anderson (859) 242-5025
Jana Cavalier
Lauren Godfray (1 888-218-4430)
Helen MacPhail / Lauren Godfray
Trainer Magazine is published by Anderson & Co Publishing Ltd.
Contact details Tel: 1 888-218-4430 Fax: 1 888-218-4206 info@trainermagazine.com www.trainermagazine.com
North America
PO Box 13248, Lexington, KY 40583-3248
14 Berwick Courtyard, Berwick St Leonard, Salisbury, Wiltshire SP3 5UA
Alan F. Balch was hired as the executive director of the California Thoroughbred Trainers in April 2010. His professional career in racing began at Santa Anita in 1971, where he advanced to the position of senior vice president of marketing and assistant general manager, and was in charge of the Olympic Games Equestrian Events in Los Angeles in 1984. He retired in the early 90s to become volunteer president of the National Equestrian Federation of the USA, as well as of the National Horse Show of Madison Square Garden. He remains president of USA Equestrian Trust, Inc.

Bill Heller is an Eclipse Award-winning author whose 27th book, Fred Hooper – The Extraordinary Life of a Thoroughbred Legend, was published last summer. His other biographies include Hall of Fame jockeys Ron Turcotte, Randy Romero and Jose Santos. Bill and his wife Marianne live near Gulfstream Park. Bill’s son Benjamin is an accomplished marathon runner in New York.
Kerrie Kavanagh is a PhD candidate (through University Of Limerick) where her research focuses on studying the equine microbiome and developing an equine autogenous probiotic. Her work as a Senior Microbiologist at the Irish Equine Centre involves running the Microbiology lab dealing with outbreaks such as Strangles, reproductive venereal pathogens, enteric investigations, parasitology, epidemiology, water & environmental monitoring & disinfectant efficacy trials for equine use.
Annie Lambert is a photojournalist based in Temecula, California. She grew up enjoying many facets of the equine industry with her veterinarian father, Dr. Willard D. Ommert, and mother, Pat North Ommert, who is an inductee of the National Cowgirl Hall of Fame. Annie has been involved in many aspects of the Thoroughbred racing industry, rode hunters and jumpers as well as reined cow horses.
Trainer Magazine is the official magazine of the California Thoroughbred Trainers. It is distributed to all ‘Trainer’ members of the Thoroughbred Horsemen’s Association and all members of the Consignors and Commercial Breeders Association, the Maryland Horse Breeders Association, the Pennsylvania Horse Breeders Association, the Alberta Thoroughbred Owners & Breeders Association and the Virginia Thoroughbred Association.

Dr. Peter W. Physick-Sheard describes himself as a clinician, not a researcher, though since health issues caused him to move out of the clinic and de-emphasize hands-on engagement in equine clinical cardiology, his time has primarily been taken up in teaching and research. His main interests are cardiovascular medicine in the performance horse, health management and industry studies with particular emphasis on epidemiologic investigations, always with a performance twist. He is a graduate of Bristol University School Of Veterinary Science and came to the University of Guelph, Canada, shortly after graduating. The atmosphere must be conducive because he only went for a year and is still there! His greatest motivators continue to be the horse and seeing young people succeed in their careers.
Ken Snyder is a current turf writer for Gallop magazine, and a turf/travel-culture writer for Kentucky Monthly magazine. His work has appeared, as well, in other publications, including Blood-Horse. He and his wife, Cassie, reside in Kuttawa, Kentucky.
Trainer Magazine (ISSN 17580293) is published 4 times a year: February, April, July and October by Anderson & Co Publishing and distributed in the USA by Modern Litho | Brown Printing, 6009 Stertzer Road, Jefferson City, MO 65101.
Periodicals postage paid at Jefferson City, MO, and additional mailing offices.
POSTMASTER: Send address changes to Trainer Magazine, Anderson & Co Publishing, PO Box 13248, Lexington, KY 40583-3248.
10 day treatment can last for months and even up to a year.

SHADAYID STUD—839± acres on both sides of Leestown Road
stall concrete block horse barns.
2—18-stall concrete block horse barns.
Rehab barn with 8 stalls and offices.
Show barn, calving barn, 3 hay barns, turn-out barn, shop and equipment building.


Manager house, 4 employee houses, and office.
FORT BLACKBURN Purchased by Will Farish as 264 acres of raw land in 1999, Mr. Farish has developed this land into an exceptional horse farm. Adjoining a division of Stonestreet Farm, it boasts an unparalleled location on Old Frankfort Pike. Horse improvements include 3 world-class 20-stall horse barns, 12+ miles of plank fencing, a covered walker, equipment/shop building. Renovated historic 2,650 SF home.
WINCHESTER FARM Location!
Location! Location! Highly developed 268 acre horse farm on highly desirable Mt. Horeb Pike and adjoining Castleton Lyons. Improvements include 6 horse barns with 78 stalls & 3 employee houses. Overlooking the Elkhorn Creek, and in a park like setting you'll discover the wonderful 4 bedroom 3.5 bath home whose lower level serves as the farm office, but suitable for living area.
MILLENNIUM FARMS— Located on desirable Paris Pike with 317 acres, 8 horse barns and 128 stalls. The 6,150 SF main residence includes 7 bedrooms and 6 full/2 half baths. Farm is complemented with 5 employee houses, yearling complex with covered 70’ round pen, & 6 horse walker. 3030 SF office was built to convert to a guest house. Concrete-based maintenance/muck removal area with newer shop with open equipment shed on each side.


305 ACRES ON GRASSY SPRINGS Turn-key Woodford County horse opera�on consis�ng of 5 concrete block barns & 94 stalls. The farm also has a 7200 SF shop with equipment shed & hay barn; a 6-horse covered walker; & 2 round pens. 2,845 SF main residence, 2 employee houses, a 1200 SF farm office. 39 paddocks and 10 fields are encompassed by well-maintained 4 plank fencing. This Kentucky bluegrass farm is a gem!

building and equipment shed.
SF home
as an office).
South Elkhorn.
Bordered by the South Elkhorn
Bill Bell (859‐621‐0607)
Muffy Lyster (859‐229‐1804)
Mary Sue Hughes (859‐619‐4770)
Allen Kershaw (859‐333‐2901) Marilyn Richardson (859‐621‐4850)
Bo Goodman (859‐509‐0582)
Bill �us�ce (859‐255‐3657)
 ERHAAB STUD—525± acres
ERHAAB STUD—525± acres
Annie Lambert meets the Californian-based trainer whose success story is a fruition of his childhood ambitions.
Kerrie Kavanagh explains why gut flora and probiotics are such a vital part of equine nutrition.


Peter W. Physick-Sheard shares his research on the possible links with EIPH and other conditions.
Bill Heller celebrates Tom Egan’s success as both a breeder and owner through 50 years of loving, working with and racing horses.


Annie Lambert talks to Dr. Michael Manno about dilemmas the Sacroiliac joint can pose and how to deal with these.

Featuring Dr. Robert and Laura Vukovich (Leave No Trace), Donato Lanni, X-Men Racing (Moira, Last Call) and Patrick O’Keefe, Kentucky West Racing (Classic Causeway).
Ken Snyder tells the story of Sandra Washington, the tack room survivor.
Ken Snyder talks to Jerry Dixon, Jr., the groom responsible for this year’s Kentucky winner


– Rich Strike; and find out what’s happened to Dixon, Jr. since the first Saturday in May.
Alan Balch – remembering where we come from.
Bill Heller asks “Does it pay to stay – should more tracks follow Oaklawn Park’s lead for incentivizing field size?”
Visit trainermagazine.com to download our current digital editions and access back issues of both European and North American Trainer.


components is its essence … elites of accomplishment and merit, like him, comfortably perform alongside all the other elites, including those of birth, inherited or self-made wealth and royalty.
Horses have brought us all together, and many of us have been lucky enough to know—and be appreciated by—some of the world’s most famous personages.
Like so many of us in racing, I’ve been horse crazy my entire life.
Some of my earliest memories are being on my dad’s shoulders, going through the livestock barns at the San Diego County Fair, and then lighting up when we got to the horse show … which, back then, was located just outside the turn at Del Mar into the backstretch, at the old 6-furlong start, long before the chute was extended to 7/8. All their horse barns back then were the original adobe, open to the public during the fair, and we could walk down the shed rows talking to the horses, petting those noses and loving the stable smells.

At least I did. My mom was appalled, of course.
She assumed, I’m certain, that I would grow out of my weird fixation. But the way those things go at certain ages, the more I was discouraged, the more obsessed I became. The fact that our family was decidedly not elite in any respect, certainly not educationally or financially, became a great opportunity for me to work at what I loved the most: taking care of the horses, to begin with, and camping at the barn whenever possible. At first, I wasn’t getting paid at all—except in getting to learn to ride by watching and listening and then riding my favorite horses without having to rent them. Lessons were out of the question
I gradually learned that the people who owned and showed and raced horses had to have the money to do it, and being able to do that myself was beyond my imagination I don’t remember ever caring. Nor do I remember ever being mistreated because
of my lowly station. In fact, it was a great bonus for me to get out of school at times to travel to shows and live in a tack room in the stables. And, as I grew older, to start getting paid actual wages for my work.
Making it through college and graduate school without having to wash dishes in the dining hall led to my loving equestrian sport in a different way and at a much different level—especially when I met Robert Strub at the Forum International Horse Show in Los Angeles (which I was managing while attending school). He offered me a position at Santa Anita.
Elite equestrian sport, racing and non-racing alike, became the rest of my distinctly non-elite life. And, I venture to say, my fellow non-elites in these sports vastly outnumber the elites.
Almost all trainers, jockeys and racing labor on the backstretch, who make the game go from hour to hour, day to day, month to month, and year to year, weren’t elite when they started out, at least by any definition except the one that counts: their merit, their specialized skills, and their commitment to horses and the sport. I remember how moved I was a decade ago when one of international racing’s most elite trainers got choked up when describing how it felt to be appointed a director of an esteemed racing association. “I’m just a trainer,” he said, as though his accomplishments and expertise didn’t qualify him to rub shoulders and contribute to deliberations alongside wealthy and powerful elite decision-makers They did. And they do.
In this greatest of all sports where the interdependence of all its critical
So it was when Victor Espinoza, the self-proclaimed “luckiest Mexican on Earth,” won the Triple Crown, and later had occasion to meet and joke with Queen Elizabeth II at Royal Ascot. Doesn’t his story sum it up? And remind most of us where we came from?

The eleventh of twelve children, born on a dairy farm in Tulancingo, Hidalgo, growing up to work in a manufacturing plant and the stables, Victor drove a bus to pay for jockey school. Anyone who has endured Mexico City traffic knows the elite skills that must have been required! He aspired to more; his skill and determination resulted in successes reserved for the very fewest of the world’s top athletes. As the famed Dr. Robert Kerlan—who treated athletes at the highest levels of every major sport—once observed, “pound for pound, jockeys are the greatest.”
When honored by the Edwin J. Gregson Foundation, which has raised over $6 million from the racing community in 20 years—of which 98% is dedicated to backstretch programs including scholarships for its children—Victor again cited his luck in achieving what he has without much school, as well as his amazement at the Gregson’s success in its scholarship program. Hundreds of backstretch community children have gone to college because of it—in fields ranging from mechanical engineering to biology, nursing, graphic design, criminal justice, life sciences, sociology and everything else.
A few are now even among the world’s elites in architecture and medicine. The backstretch teaches tenacity.
And isn’t that just one reason why her late Majesty the Queen loved horses, racing, and its community, above all her other pursuits?


Trainer John Sadler has aimed at a career in the equine industry since he was a small child.
His resolve landed him exactly where he needed to be.
Who knew that a little boy’s encounter with horses in a field adjacent to a family’s summer vacation home would set a course toward a lifelong career with horses? That young boy was California-based trainer John Sadler.
It was Sadler’s connection to horses that kept him on course to become a successful horseman. “I always wanted to work with horses,” he recalled.
The trainer’s equine experiences evolved from simple riding lessons to appease his mother, to showing hunters and jumpers and then, on to a natural progression within the Thoroughbred racing industry. Each chapter of Sadler’s equine journey has been fruitful.

He was an outstanding rider in the show ring and now sits among the best trainers in the racing industry. As of October 17, 2022, Sadler has amassed earnings of $141,103,975. Horses like Accelerate, Stellar Wind, Switch, Higher Power and current superstar Flightline have greatly enhanced his coffers.
While Sadler seems a humble guy, his accumulating milestones are worth boasting about. The kid attracted to horses at first glance is definitely making the most of his passion.

Sadler was born in Long Beach, California, but was raised in nearby Pasadena. His family was summering at a house near the beach in Palos Verdes when his equine passion bloomed.
“We spent one summer at the beach, and some people had horses in their backyard,” Sadler recalled. ”I told my mother I’d like to ride the horses, but she told me I had to take lessons if I wanted to ride. So, when I was very young, I took riding lessons in Palos Verdes.”
When summer ended, the new equestrian wanted to keep up with his lessons and found himself riding at Flintridge Riding Club in La Canada, in the shadow of the Rose Bowl, all through high school. Riding with Jimmy A. Williams, a renowned horseman, helped Sadler excel at riding show horses.

Dianne Grod, a respected trainer and rider of Gran Prix jumpers now retired and living in Ocala, Florida, remembered Sadler’s ability. “He rode hunters well, he rode the jumpers well and he equitated well,” Grod said. “And back then, everybody did all three divisions on the same horse.”
During his high school years, Sadler competed for a position on the United States Equestrian Team during their West coast screening trials held at Foxfield Riding School at Lake Sherwood, outside of Los Angeles.
During Sadler’s show jumping era, his parents became involved in Thoroughbred racing on a small scale.
“My parents had a fractional interest in a couple of racehorses with a group from Pasadena and San Marino,” Sadler explained. “Impossible Stables, Inc., was a fun group of people who were social friends. I would go out to the track with my parents and
watch the horses run, so I got involved with the track early.”
Sadler admits the years have somewhat run together, making exact dates hard to recall, but during a couple of high school summers he found himself walking hots at Del Mar.
His racetrack career had begun.

With his family spending a couple summers near Oceanside, Sadler headed to the track and a job walking hots for now retired trainer Tom Pratt, (Chiapas, Mexico). Pratt was a stepping stone on Sadler’s career path.
“He was a good and talented employee,” Pratt offered. That was high praise for a teenaged hotwalker learning the ropes.
Once he graduated high school, Sadler headed to the University of Oregon in Eugene. The Liberal Arts/English major selfadmittedly that he “was not really a focused student.” He did, however, confess to taking half of the fraternity house to Portland Meadows racetrack one day, which was “a good trip.”
It was not hard to believe that the young horseman made a beeline back to the track following college. His learning was more focused around the horses, and he began studying the industry from within.
Sadler went to work as an assistant to veterinarian Dr. Jack Robbins during the 1970s. Robbins, who passed away in 2014, remains an iconic figure in the history of racing.

“I was his assistant for a couple of years,” Sadler said. “I always credit him a lot; I learned a lot from him. He was a great guy… a successful owner, a very successful veterinarian, and he was one of the founders of the Oak Tree Racing Association. Not only did he have the veterinary knowledge, he had a good overview of the whole game.”
Sadler did not give serious consideration to becoming a veterinarian, but he did learn a lot from Robbins and the doctor’s top tier clientele.
“It was just fun to go into all these barns, every single day,” Sadler reminisced. “You’re talking about names like Noble Threewitt, Lester Holt, Joe Manzi, Ron McAnally, Gary Jones, Warren Stute, John Sullivan, Buster Millerick…I mean, all the guys that were kind of the backbone of California. I always tried to take something from all of them—all of those great trainers.”


After working for Robbins, Sadler went to work for David Hofmans as an assistant trainer for a year or more. “There is no nicer person than Dave,” Sadler recalled. The boss also appreciated his assistant.

“He was great—a real help to me,” Hofmans said of Sadler. “Working with Jack Robbins gave him an overall picture of what was going on [with veterinary issues]. Dr. Robbins worked for many people, so John got to learn and understand medications and stuff. John was a very smart guy, very astute, and he paid attention to detail. He was great, and I was sad to see him leave.”
In about 1978, Sadler had the opportunity to oversee the late Eddie Gregson’s Northern California string—his first job training on his own.
“Eddie had a lot of horses at that time and was looking to have a trainer up north,” Sadler explained. “He proposed the idea of me going up there on his behest; I trained up there for a year or a year and a half.”
Tom Pratt decided to retire about that time and kindly offered Sadler an option of taking over a few of his horses.
“Pratt said he had four or five horses that I could train,” Sadler said. “I came back to Southern California and of the 30 horses I had up north, about four or five were good enough to come down here, so that’s how I got started here. These guys were all so good to me.”

Pratt’s trust in Sadler was evident.
“When I quit training, I turned over most of my clients to him,” he recalled. “I also bought a few horses with partners and gave him those to train. I had confidence in him and was happy to give him a big leg up to what has become a very successful career.”
His first year as a licensed trainer Sadler ran Gregson’s horses as well as a few starters of his own. His 1978 Equibase records showed four starters with one running third and earnings of $2,700. But, that was just the beginning. He currently has 2713 wins, and counting.
Sadler’s first winner was Top Taker (Top Conference). His record has grown exponentially over the past 44 years as a trainer. As he put it: “As the years progressed, I got better stock, obviously. It’s been kind of a natural progression.”












ABOVE: Accelerate, ridden by Joel Rosario, wins the 2018 Breeders’ Cup Classic at Churchill Downs.

LEFT: Stellar Wind and Victor Espinoza hold off Beholder to win the first of two Clement L. Hirsch Stakes at Del Mar, 2016.

BELOW LEFT: Higher Power ridden by Flavien Prat, wins the 2019 Pacific Classic at Del Mar, a year after Accelerate wins the same race.
That progression included a slew of graded stakes winners. Accelerate (Lookin At Lucky)—the top earner to date with $6,692,480—was the Eclipse Award 2018 Champion Older Dirt Male. His accolades include winning five Gr. 1 races and the 2018 Breeders’ Cup Classic. The stallion now stands at Lane’s End Farm in Kentucky. Sadler has several of his first crop two-year-olds in training.
“I’ve got four or five nice ones,” he revealed. “One ran third the other day; they are good looking prospects.”
Stellar Wind (Curlin) was a star for Sadler—being his second highest earner to date with $2,903,200. Owner Hronis Racing sold her through the 2017 Keeneland November Mixed Sale for $6 million, going to M.V. Magnier/Coolmore. Trainer Chad Brown ran her in the Pegasus World Cup Invitational Stakes (G1) the following January. The mare finished out of the money after a bobbled start in her final race.

Switch (Quiet American) earned $1,479,562 for owner CRK Stable. She was twice second and once third in the Breeders’ Cup Filly & Mare Sprint between 2010 and 2012. She was sold at the 2012 Fasig-Tipton Kentucky Fall Mixed sale for $4.3 million to Moyglare Stud Farm.
“She almost beat Zenyatta one day at Hollywood Park,” Sadler recalled. “She lost narrowly, by a head or something. One of the times she ran second at the Breeders’ Cup, she was beaten by Musical Romance, who was ridden by my assistant trainer, Juan Leyva.”
Higher Power (Medaglia D’Oro) added $1,594,648 to the Hronis Racing coffers. He won five of his 20 lifetime starts, including the 2019 Pacific Classic (G1) as well as running third in the 2019 Breeders’ Cup Classic. The bay now stands at Darby Dan Farm in Kentucky.




Sadler currently has Flightline (Tapit), arguably the best dirt horse in the world, and ranked globally a close second to champion British turf star Baaeed (Sea The Stars (IRE). Flightline is (at the time of writing) five-for-five and a likely starter in the Breeders’ Cup Classic. The colt, owned by Hronis Racing, Siena Farm, Summer Wind Equine, West Point Thoroughbreds and Woodford Racing was a $1 million yearling purchase. And, he was more than worth the price.

Flightline has proven his prowess with amazing ease so far; competitors are not able to touch him. With Flavien Prat, his only jockey to date, the four-year-old won his first three starts, last year, by a total of 37 lengths.

In June this year, he won his fourth start in the Metropolitan Mile at Belmont by six lengths. His most mind-boggling win
came when he dominated his rivals with a nearly 20-length victory in the Pacific Classic (G1) at Del Mar, effectively extinguishing doubts that he could go the mile and a quarter. Prat looked over his shoulder when he couldn’t hear hoof beats behind him and eased his colt to the wire.
Admirers calculate he has won his five races by a total of more than 62 lengths. Let that sink in.
Flightline may have dominated the 2021 Triple Crown series had he not been injured while being started as a two-year-old. The colt was in Ocala when the latch on a stall door compromised his hind leg.
“I wasn’t there, but it was at least six to eight inches,” Sadler said of the wound. “It was pretty deep, pretty ugly. That was one of the reasons he didn’t get to me until later.”


Flightline with a six-length victory in the $1 million Metropolitan Mile, 2022.

Flightline’s effective stride probably has a lot to do with his effortless proficiency over the racetrack. But with all his talent, the colt is not a piece of cake to train. His personality could be called cheeky, exuberant or brazen on any given day.
“He’s a very tough horse to gallop,” Sadler said. “In the barn he’s not a pussycat—he’s all horse. He’s all man, that’s for sure.”

“He really does have a big stride,” Sadler added. “He’s just one of those exceptional horses that comes along very rarely in the Thoroughbred world. I’m just trying to enjoy him every single day, because he’s that special. It’s really exciting; I feel very blessed to have him.”
Flightline’s future will be determined following his run in the Breeders’ Cup Classic. According to Sadler, the ownership group is an agreeable lot. Upon retirement, he will stand at Lane’s End Farm.

“The decision will be made after the Breeders’ Cup,” Sadler confirmed. “You want to see where the horse is after that race. And it’s not like anybody has a closed mind, one way or the other. We’ll wait and see what happens.”

HE’S JUST ONE OF THOSE EXCEPTIONAL HORSES THAT COMES ALONG VERY RARELY IN THE THOROUGHBRED WORLD I’M JUST TRYING TO ENJOY HIM EVERY SINGLE DAY, BECAUSE HE’S THAT SPECIAL. IT’S REALLY EXCITING; I FEEL VERY BLESSED TO HAVE HIM.”
SADLER ON CURRENT STABLE STAR FLIGHTLINEJohn with Kosta Hronis.

It seems obvious that Sadler truly enjoys horses and particularly training racehorses. His barn is a well-oiled machine, with some employees that have been with him 20 and even 30 years. His barn is a team, a group effort.


“You want to like your employees because you spend so much time with them out here at the track,” he said. “I’m really pleased—I’ve got a really good crew; I’m blessed that way. Horses are hard; there are no cutting corners—no way to take two days off. It doesn’t work that way. I think a lot of guys like the routine. They know what’s expected of them; and if they like to work, it’s a great job.”
Sadler is not a man who toots his own horn. Hofmans remembers him as “a quiet guy” who always paid attention. John Sadler’s modesty seems refreshing in such a competitive industry.
California-based trainer John Sadler has many accolades to his credit. One event that has gone fairly unnoticed through the years is a match race that took place in 1991.
The race was an idea that spun out of the racing office at the time. They wanted to match the three-time Quarter Horse 870-yard champion Griswold with a Thoroughbred sprinter.
“They proposed matching a really good half-mile horse from Los Alamitos, which really dominated over there,” Sadler said. “At that time, I had three or four really good sprinters. I thought I had the right horse for it—a horse called Valiant Pete.”
The race, boasting a $100,000 winner-take-all purse, was held April 20 at Santa Anita. The race was run at a distance of four furlongs (880 yards) and is remembered as “thrilling” to the few who remember it.

An obituary for Griswold (Merridoc), who died at the age of 25 in 2011, described the action:
“…the pair raced neck and neck throughout, with the Thoroughbred leading all the way to a world record-tying clocking of 44 1/5 seconds.”
Griswold later found revenge by beating Valiant Pete in the Marathon Handicap at Los Alamitos.
HORSES ARE HARD; THERE ARE NO CUTTING CORNERS— NO WAY TO TAKE TWO DAYS OFF. IT DOESN’T WORK THAT WAY. I THINK A LOT OF GUYS LIKE THE ROUTINE. THEY KNOW WHAT’S EXPECTED OF THEM; AND IF THEY LIKE TO WORK, IT’S A GREAT JOB.”







Equine studies to date have shown that probiotic strains can offer an advantageous approach to minimizing disturbances in the gut microbial populations, repair these deficiencies—should they occur—and re-establish the protective role of the healthy gut microbiome. Other probioticassociated health benefits include reducing diet-related diseases such as colic and laminitis, preventing diarrhea, conferring host resistance to helminth infection, improving stress-related behavioral traits (e.g., locomotion) and even promote the development of an effective gut-brain communication pathway.

Probiotics have been used by humans for more than 5,000 years with their development closely linked to that of dairy products and fermented foods. Today, probiotics are seen as an excellent non-pharmaceutical way to improve the health of both humans and animals, and there is a plethora of products to choose from. But what exactly is a probiotic, and how does it work? Why would your horse need one? What types of probiotics are available for horses? These are all questions that horse trainers ask frequently, which we will attempt to answer here.
The Equine Gut Microbiome Probiotics and the equine microbiome can benefit from a valuable symbiotic relationship; probiotics are seen as a restorative treatment modality for the gut, to re-establish the bacterial populations there and also to re-establish the protective role that the health gut microbiome confers to the host. But when we discuss the equine microbiome, what are we really talking about?
The gut microbiota/microbiome can be categorized by anatomical location such as the oral microbiota/microbiome in the mouth and the intestinal microbiota/microbiome in the intestines, etc. Therefore, the gut microbiome pertains to the microbiota in the gastrointestinal tract. This population of microorganisms (bacteria, fungi, viruses, protozoa) is referred to as the “microbiota” of the gut, while the term “gut microbiome” refers to the genetic material associated with these microorganisms. The microbiome can be defined as the sum of the microbes and their genomic elements in a particular environment. If we look at the definition of the microbiome having the propensity to an equation, then any equation must be balanced; to maintain that balance is key. If the microbial community exists in an environment in a balanced state, then any upset or disturbance to the microbial populations will cause the balance to shift (known as dysbiosis). To maintain the balance, we need to firstly understand the way the microorganisms exist within their community (i.e., their microorganism-to-microorganism interactions and also microorganism-to-environment interactions) and secondly, their functioning role. If we can understand their (microorganism) position and role, then we can maintain the balance or re-establish the balance if a shift occurs.
It is no surprise that the health maintenance of the racehorse is a top priority for trainers. And probiotics can be used as a treatment modality to manipulate the gut microbiome to improve or maintain health.
The human intestinal microbiome is now recognized as an organ and likewise, the equine intestinal microbiome is deemed an “organ” of the body and is vital for the breakdown of complex food and subsequent release of energy, protection against the pathogenic bacterial colonization and in regulating the immune system and metabolic functions. There has been much debate regarding the content of the healthy equine microbiome, and even to deduce what “healthy” or “normal” is requires a level of understanding of the microbiota associated with healthy horses. This question has been posed by many researchers and frankly has yet to be answered with certainty. There are many reasons why the “normal” microbiota keeps eluding us; and this can be attributed to the many reasons as to why the gut microbiota (of a healthy horse) can be affected (see Fig. 1). It is thought that the diversity of the human gut microbiota and the general assembly of microbial communities within the gut (with the dominant phyla being classed as belonging to Firmicutes and Bacteroidetes) is a shared hypothesis across most species (i.e., humans and animals share a similar gut microbiome structure). Firmicutes and Bacteroidetes have been shown to constitute the main dominant phyla in equine, bovine, canine and feline gut microbiome studies indicating the cruciality of the role they play in the maintenance of a healthy microbial ecology in the gastrointestinal tract. Several studies do agree that dominant phyla of the equine gut microbiota are obligate anaerobes: the grampositive Firmicutes and the gram-negative Bacteroidetes; other phyla are identified as Proteobacteria, Verrucomicrobia, Actinobacteria, Euryarchaeota, Fibrobacteres and Spirochaetes. Ninety-five percent of the Firmicutes phyla contains the Clostridia genus in addition to genera related to gut health such as Lachnospiraceae, Faecalibacterium and Ruminococcaceae. The other main dominant phyla, Bacteroidetes, on the other hand contains a large variety of the genus.
The role of the gut intestinal microbiota serves to protect and prevent disease. The gut microbiota has several purposes: prevention of pathogen colonization by competing for nutrients, enrichment and maintenance of the intestinal barrier—their ability to renew gut epithelial cells and repair damage to the mucosal barrier, the breakdown of food and releasing energy and nutrients, such as synthesizing vitamins D and K and also conserving and restoration of the immune system by the formation of antimicrobial metabolites and blocking access to the binding sites of the mucosal wall. The gut microbiota is also thought to play some role of influencing the neuro-active pathways that affect behavior. It is not surprising to see that gut disorders and gastrointestinal diseases can arise when gut dysbiosis occurs. The role of the gut microbiota may have even more importance than is realized and may have a role to play with developing illness or disease later in life.

STRESS (TRAVEL, EXERCISE, WEANING, ETC.)
DISEASE (LAMINITIS, COLIC, COLITIS)
THE ROLE OF THE GUT INTESTINAL MICROBIOTA SERVES TO PROTECT AND PREVENT DISEASE. THE GUT MICROBIOTA HAS SEVERAL PURPOSES.”

Beneficial
The microbial colonization of the intestinal tract begins at birth. The foal begins its colonization through contact with the microbiota of the mare’s vaginal and skin surfaces plus the surrounding environments to which the foal is exposed and reaches a relatively stable population by approximately 60 days in age. It is perhaps a fight for dominance to achieve establishment in the gut among the bacterial populations that sees the foal’s microbiota as being more diverse and quick to change when compared to that of the older horse. The subsequent colonization of the intestinal tract will reflect the foal’s diet, changing environment, introduction to other animals, aging and health.
The word probiotic is of Greek origin meaning “for life”, and the WHO/FAO have defined probiotics as “live microorganisms which when administered in adequate amounts confer a health benefit on the host”. People have long believed that exposure to nonpathogenic microorganisms can benefit the health of humans and animals. The thinking behind this is that daily consumption of sufficient numbers of “good” microorganisms (either bacteria or fungi) can maintain a healthy population of microorganisms in the gut and benefit overall health.
Probiotics are used to manipulate the bacterial populations of the gut in order to re-establish the delicate microbial balance there which, in turn, confers health benefits on the host. As the benefits associated with some of the “good” bacteria within the gut became known, these were referred to as probiotic bacteria.
There are four main mechanisms by which probiotics are thought to exert their effects.
1. By inhibiting pathogen colonization in the gut through the production of antimicrobial metabolites or by competitive exclusion; in other words, they prevent the “bad” bacteria from growing in the gut.
2. By protecting or re-stabilizing the commensal gut microbiota, probiotics can be a means to re-establish the balance of the gut microbial populations.
3. By protecting the intestinal epithelial barrier, they maintain the health of the intestinal wall.
4. By inducing an immune response, probiotics can boost the immune system and help prevent disease.
If we consider the definition of a probiotic as “live non-pathogenic microorganisms that, when administered in adequate amounts, confer a health benefit on the host”, then this reference to “adequate amounts” must be emphasized, and the dose administered is critical to ensure that the probiotic has the desired effect. For horses, we must consider the route through the digestive tract that the probiotic strains must travel to arrive at their destination

PEOPLE HAVE LONG BELIEVED THAT EXPOSURE TO NON-PATHOGENIC MICROORGANISMS CAN BENEFIT THE HEALTH OF HUMANS AND ANIMALS.”



is a distance over 49 feet (15 meters) long. It is a race for survival! The gastrointestinal system has many obstacles along the passage such as the acidic stomach environment and the dangers of exposure to bile and digestive enzymes, in which they must survive. The initial dose of “live” probiotic strains is therefore crucial to ensure survival in the gut. Prebiotics are ingredients such as carbohydrates and fibre, which promote the growth of these probiotic bacterial/ yeast strains in the gut. Prebiotics are essentially the food for the probiotic strains and can help form a symbiotic relationship with the probiotic to improve the overall health status of the horse.
Why would you need to give your horse a probiotic? Gut dysbiosis is a fluctuation or disturbance in the population of microorganisms of the gut, which may be linked to a wide range of diseases in horses. Gut dysbiosis can be caused by many factors ranging from dietary changes, antibiotics, disease, intense exercise and training, age, worms, environment, travel, or even minor stress events—resulting in major consequences such as colic. Dysbiosis is generally associated with a reduction in microbial species diversity.
Diet is one of the major factors contributing to gut dysbiosis. Unlike the ruminant cattle and sheep that use foregut fermentation, horses are hindgut fermenters. The large intestine is the main area where fermentation occurs. The horse utilizes the microbial enzymes of the hindgut microbial population in the colon and cecum to break down the plant fibres (cellulose fermentation) sourced mainly from grasses and hay. The horse itself does not possess the hydrolytic enzymes that are required to break the bonds of the complex structures of the plant carbohydrates (in the form of celluloses, hemicelluloses, pectins) and starch; so therefore, it strongly relies on the microbiota present to provide those critical enzymes required for digestion. The main phyla Firmicutes and Bacteroidetes possess enzymes capable of breaking down the complex carbohydrates (such as starch and cellulose). Research has shown that forage-based diets (grasses and hay) promote the
most stable gut microbiomes, but ultimately the equine athlete requires far more energy than a forage-based diet can supply. Supplementing the diet with concentrates containing starch such as grain, corn, barley and oats can affect the number and type of bacteria in the gut. Optimizing diet composition is so important as carbohydrate overload—as seen with high-starch diets (>1g/kg body weight per meal)—can change the populations of bacteria in the gut, alter pH, upset digestion and the gut environment, and ultimately result in diseases such as colitis, colic and laminitis. The correct diet is essential for maintaining the delicate balance of bacterial populations. Probiotics can be used to either replace the bacteria missing in the gut and/or can help maintain the delicate microbial balance even in the face of adversity such as abrupt dietary changes, antibiotic treatment and stress.
What types of probiotics are available for horses? There are several probiotic products on the market, and most are in powder or liquid form. There are two main categories of probiotics: generic and autogenous.

1. Generic probiotics are off-the-shelf products that contain specific strains of bacterial or yeast, singularly or in combination. The Lactobacillus and Bifidobacterium families, Enterococci and yeasts such as Saccharomyces cerevisae and boulardii are the most common equine probiotic strains. Advantages of generic probiotics are that they are widely available, easy to administer, and they may be beneficial to horse health (if the strains are alive in sufficient numbers).
2. Autogenous probiotics are specifically formulated using bacteria obtained from the horse’s own fecal sample and, as such, are uniquely adapted to that individual animal. These host-adapted bacteria are more likely to survive in the gut than non-adapted generic strains and can quickly replenish absent or low levels of bacteria unique to the individual horse, thus maintaining health.







World's Your Oyster, a three-year-old Thoroughbred mare, presented at the veterinary hospital for clinical examination. She won her maiden start as a two-year-old and placed once in two subsequent starts. After training well as a three-year-old, she failed to finish her first start, easing at the top of the stretch, and was observed to fade abruptly during training. Some irregularity was suspected in heart rhythm after exercise. Thorough clinical examination, blood work, ultrasound of the heart and an ECG during rest and workout revealed nothing unusual.
Returning to training, Oyster placed in six of her subsequent eight starts, winning the last two. She subsequently died suddenly during early training as a four-year-old. At post-mortem, diagnoses of pulmonary hemorrhage and exercise-induced pulmonary hemorrhage were established—a very frustrating and unfortunate outcome.
Across the racing world, a case like this probably occurs daily. Anything that can limit a horse's ability to express its genetic potential is a major source of anxiety when training. The possibility of injury and lameness is the greatest concern, but a close second is respiratory disease, with bleeding from the lungs

(most often referred to as exercise induced pulmonary [lung] hemorrhage or EIPH) being high on the list.
EIPH is thought to occur in as many as 85 percent of racehorses, and may initially be very mild without obvious clinical consequences. In some cases it can be associated with hemorrhage of sufficient severity for blood to appear at the nostrils, even at first occurrence. In many racing jurisdictions this is a potentially career-ending problem. In these horses, an impact on performance is unquestionable. Bleeding from the lungs is the reason for the existence of “Lasix programs,” involving pre-race administration of a medication considered to reduce hemorrhage. Such programs are controversial—the justifications for their existence ranging from addressing welfare concerns for the horse to dealing with the performance impacts.
Much less frequently encountered is heavy exercise-associated bleeding from the nostrils (referred to as epistaxis), which can sometimes be accompanied by sudden death, during or shortly after exercise. Some horses bleed heavily internally and die without blood appearing at the nostrils. Hemorrhage may only become obvious when the horse is lying on its side, or not until post-mortem. Affected animals do not necessarily have
Dr. Peter W. Physick-Sheard, BVSc, FRCVS, explores preliminary research and hypotheses, being conducted by the University of Guelph, to see if there is a possibility that these conditions are linked and what this could mean for future management and training of Thoroughbreds.
any history of EIPH, either clinically or sub-clinically. There is an additional group of rare cases in which a horse simply dies suddenly, most often very soon after work and even after a winning performance, and in which little to nothing clearly explains the cause on post-mortem. This is despite the fact most racing jurisdictions study sudden death cases very closely.

EIPH is diagnosed most often by bronchoscopy—passing an endoscope into the lung after work and taking a look. In suspected but mild cases, there may not be sufficient hemorrhage to be visible, and a procedure called a bronchoalveolar lavage is performed. The airways are rinsed and fluid is collected and examined microscopically to identify signs of bleeding. Scoping to confirm diagnosis is usually a minimum requirement before a horse can be placed on a Lasix program.
At the University of Guelph, we are working on the hypothesis that most often they are not different—that it’s degrees of the same condition, or closely related conditions perhaps with a
common underlying cause. We see varying clinical signs as being essentially a reflection of severity and speed of onset of underlying problems.
Causes in individual cases may reflect multiple factors, so coming at the issues from several different directions, as is the case with the range of ongoing studies, is a good way to go so long as study subjects and cases are comparable and thoroughly documented. However, starting from the hypothesis that these may all represent basically the same clinical condition, we are approaching the problem from a clinical perspective, which is that cardiac dysfunction is the common cause.
Numerous cardiac disorders and cellular mechanisms have the potential to contribute to transient or complete pump (heart) failure. However, identifying them as potential disease candidates does not specifically identify the role they may have played, if any, in a case of heart failure and in lung hemorrhage; it only means that they are potential primary underlying triggers. It isn't possible for us to be right there when a hemorrhage event occurs, so almost invariably we are left looking at the outcome— the event of interest has passed. These concerns influence the approach we are taking.
The superlative performance ability of a horse depends on many physical factors:
• Huge ventilatory (ability to move air) and gas exchange capacity
• Body structure including limb length and design – allows it to cover ground rapidly with a long stride
• Metabolic adaptations – supports a high rate of energy production by burning oxygen, tolerance of severe metabolic disruptions toward the end of race-intensity effort
• High cardiovascular capacity – allows the average horse to pump roughly a brimming bathtub of blood every minute
At race intensity effort, these mechanisms, and more, have to work in coordination to support performance. There is likely not much reserve left—two furlongs (400m) from the winning post—even in the best of horses. There are many wild cards, from how the horse is feeling on race day to how the race plays out; and in all horses there will be a ceiling to performance. That ceiling—the factor limiting performance—may differ from horse to horse and even from day to day. There’s no guarantee that in any particular competition circumstances will allow the horse to perform within its own limitations. One of these factors involves the left side of the heart, from which blood is driven around the body to the muscles.


The cardiovascular system of the horse exhibits features that help sustain a high cardiac output at peak effort. The feature of concern here is the high exercise pressure in the circulation from the right ventricle, through the lungs to the left ventricle. At intense effort and high heart rates, there is very little time available to fill the left ventricle—sometimes as little as 1/10 of a second; and if the chamber cannot fill properly, it cannot empty properly and cardiac output will fall. The circumstances
required to achieve adequate filling include the readiness of the chamber to relax to accept blood—its ‘stiffness.’ Chamber stiffness increases greatly at exercise, and this stiffened chamber must relax rapidly in order to fill. That relaxation seems not to be sufficient on its own in the horse at high heart rates. Increased filling pressure from the circulation draining the lungs is also required. But there is a weak point: the pulmonary capillaries.
These are tiny vessels conducting blood across the lungs from the pulmonary artery to the pulmonary veins. During this transit, all the gas exchange needed to support exercise takes place. The physiology of other species tells us that the trained lung circulation achieves maximum flow (equivalent to cardiac output) by reducing resistance in those small vessels. This process effectively increases lung blood flow reserve by, among other things, dilating small vessels. Effectively, resistance to the flow of blood through the lungs is minimized. We know this occurs in horses as it does in other species; yet in the horse, blood pressure in the lungs still increases dramatically at exercise.
If this increase is not the result of resistance in the small vessels, it must reflect something else, and that appears to be resistance to flow into the left chamber. This means the entire lung circulation is exposed to the same pressures, including the thin-walled capillaries. Capillaries normally work at quite low pressure, but in the exercising horse, they must tolerate very high pressures. They have thin walls and little between them, and the air exchange sacs in the lung. This makes them vulnerable. It's not surprising they sometimes rupture, resulting in lung hemorrhage.
Recent studies identified changes in the structure of small veins through which the blood flows from the capillaries and on toward the left chamber. This was suspected to be a pathology and part of the long-term consequences of EIPH, or perhaps even part of the cause as the changes were first identified in EIPH cases. It could be, however, that remodelling is a normal response to the very high blood flow through the lungs—a way of increasing lung flow reserve, which is an important determinant of maximum rate of aerobic working.
The more lung flow reserve, the more cardiac output and the more aerobic work an animal can perform. The same vein changes have been observed in non-racing horses and horses without any history or signs of bleeding. They may even be an indication that everything is proceeding as required and a predictable consequence of intense aerobic training. On the other hand, they may be an indication in some horses that the
rate of exercise blood flow through their lungs is a little more than they can tolerate, necessitating some restructuring. We have lots to learn on this point.
If the capacity to accommodate blood flow through the lungs is critical, and limiting, then anything that further compromises this process is likely to be of major importance. It starts to sound very much as though the horse has a design problem, but we shouldn't rush to judgement. Horses were probably not designed for the very intense and sustained effort we ask of them in a race. Real-world situations that would have driven their evolution would have required a sprint performance (to avoid ambush predators such as lions) or a prolonged slower-paced performance to evade predators such as wolves, with only the unlucky victim being pushed to the limit and not the entire herd.
There is another important element to this story. High pressures in the capillaries in the lung will be associated with significant movement of fluid from the capillaries into lung tissue spaces. This movement in fact happens continuously at all levels of effort and throughout the body—it's a normal process. It's the reason the skin on your ankles ‘sticks’ to the underlying structures when you are standing for a long time. So long as you keep moving a little, the lymphatic system will draw away the fluid.
In a diseased lung, tissue fluid accumulation is referred to as pulmonary edema, and its presence or absence has often been used to help characterize lung pathologies. The lung lymphatic system can be overwhelmed when tissue fluid is produced very rapidly. When a horse experiences sudden heart failure, such as when the supporting structures of a critical valve fail, one result is massive overproduction of lung tissue fluid and appearance of copious amounts of bloody fluid from the nostrils.


The increase in capillary pressure under these conditions is as great as at exercise, but the horse is at rest. So why is there no bloody fluid in the average, normal horse after a race? It’s because this system operates very efficiently at the high respiratory rates found during work: tissue fluid is pumped back into the circulation, and fluid does not accumulate. The fluid is pumped out as quickly as it is formed. An animal’s level of physical activity at the time problems develop can therefore make a profound difference to the clinical signs seen and to the pathology.

LEFT: An ECG from a racehorse shortly after crossing the finishing line. In this case the horse is exhibiting serious disturbances of heart rhythm. Interval between beats varies constantly and even when interval appears stable, the conformation of the waveforms is abnormal and variable. Waveform height also varies constantly. This horse returned to normal heart rhythm spontaneously as heart rate fell and continued to race successfully for the following year. There was no opportunity to test this horse for bleeding. However, no clinical signs were observed and had the horse not been undergoing research observation, the arrhythmia would not have been detected. The significance of these variations in the horse remains poorly understood. Similar variations under exercise conditions in humans would be regarded as pathological.

Image Dr. Peter Physick-Sheard, University of Guelph.
If filling the left ventricle and the ability of the lungs to accommodate high flow at exercise are limiting factors, surely this affects all horses. So why do we see such a wide range of clinical pictures, from normal to subclinical hemorrhage to sudden death?
Variation in contributing factors such as type of horse, type and intensity of work, sudden and unanticipated changes in work intensity, level of training in relation to work and the presence of disease states are all variables that could influence when and how clinical signs are seen, but there are other considerations.
Although we talk about heart rate as a fairly stable event, there is in fact quite a lot of variation from beat to beat. This is often referred to as heart rate variability. There has been a lot of work performed on the magnitude of this variability at rest and in response to various short-term disturbances and at light exercise in the horse, but not a lot at maximal exercise. Sustained heart rate can be very high in a strenuously working horse, with beats seeming to follow each other in a very consistent manner, but there is in fact still variation.
Some of this variation is normal and reflects the influence of factors such as respiration. However, other variations in rate can reflect changes in heart rhythm. Still other variations may not seem to change rhythm at all but may instead reflect the way electrical signals are being conducted through the heart.
These may be evident from the ECG but would not appear abnormal on a heart rate monitor or when listening. These variations, whether physiologic (normal) or a reflection of abnormal function, will have a presently, poorly understood influence on blood flow through the lungs and heart—and on cardiac filling. Influences may be minimal at low rates, but what happens at a heart rate over 200 and in an animal working at the limits of its capacity?
Normal electrical activation of the heart follows a pattern that results in an orderly sequence of heart muscle contraction, and that provides optimal emptying of the ventricles. Chamber relaxation complements this process.
An abnormal beat or abnormal interval can compromise filling and/or emptying of the left ventricle, leaving more blood to be discharged in the next cycle and back up through the lungs, raising pulmonary venous pressure. A sequence of abnormal beats can lead to a progressive backup of blood, and there may not be the capacity to hold it—even for one quarter of a second, a whole cardiac cycle at 240 beats per minute.
For a horse that has a history of bleeding and happens to be already functioning at a very marginal level, even minor disturbances in heart rhythm might therefore have an impact.
ABOVE: Microscope section of lung tissue from a horse that died in a severe episode of bleeding. Many alveoli (air sacs) and small airways are filled with red blood cells. Image courtesy Dr. J. Caswell, University of Guelph.

Horses with airway disease or upper airway obstructions, such as roarers, might find themselves in a similar position. An animal that has not bled previously might bleed a little, one that has a history of bleeding may start again, or a chronic bleeder may worsen.
Relatively minor disturbances in cardiac function, therefore, might contribute to or even cause EIPH. If a horse is in relatively tough company or runs a hard race, this may also contribute to the onset or worsening of problems. Simply put, it's never a level playing field if you are running on the edge.
It has been suspected for many years that cases of horses dying suddenly at exercise represent sudden-onset cardiac dysfunction— most likely a rhythm disturbance. If the rhythm is disturbed, the closely linked and carefully orchestrated sequence of events that leads to filling of the left ventricle is also disturbed. A disturbance in cardiac electrical conduction would have a similar effect, such as one causing the two sides of the heart to fall out of step, even though the rhythm of the heart may seem normal.
The cases of horses that bleed profusely at exercise and even those that die suddenly without any post-mortem findings can be seen to follow naturally from this chain of events. If the changes in heart rhythm or conduction are sufficient, in some cases to cause massive pulmonary hemorrhage, they may be sufficient in other cases to cause collapse and death even before the horse has time to exhibit epistaxis or even clear evidence of bleeding into the lungs.


If these events are (sometimes) related, why is it that some horses that die of pulmonary hemorrhage with epistaxis do not show evidence of chronic EIPH? This is one of those $40,000 questions. It could be that young horses have had limited opportunity to develop chronic EIPH; it may be that we are wrong and the conditions are entirely unrelated. But it seems more likely that in these cases, the rhythm or conduction disturbance was sufficiently severe and/or rapid in onset to cause a precipitous fall in blood pressure with the animal passing out and dying rapidly.
In this interpretation of events, the missing link is the heart. There is no finite cutoff at which a case ceases to be EIPH and becomes pulmonary hemorrhage. Similarly, there is no distinct point at which any case ceases to be severe EIPH and becomes EAFPH (exercise-associated fatal pulmonary hemorrhage). In truth, there may simply be gradation obscured somewhat by variable definitions and examination protocols and interpretations.
It seems from the above that death should most likely take place during work, and it often does, but not always. It may occur at rest, after exercise. Death ought to occur more often in racing, but it doesn't.
The intensity of effort is only one factor in this hypothesis of acute cardiac or pump failure. We also have to consider factors such as when rhythm disturbances are most likely to occur (during recovery is a favorite time) and death during training is more often a problem than during a race.
A somewhat hidden ingredient in this equation is possibly the animal's level of emotional arousal, which is known to be a risk factor in humans for similar disturbances. There is evidence that emotions/psychological factors might be much more important in horses than previously considered. Going out for a workout might be more stimulating for a racehorse than a race because before a race, there is much more buildup and the horse has more time to adequately warm up psychologically. And then, of course, temperament also needs to be considered. These are yet further reasons that we have a great deal to learn.
These problems are something we cannot afford to tolerate, for numerous reasons—from perspectives of welfare and public perception to rider safety and economics. Our aim is to increase our understanding of cardiac contributions by identifying sensitive markers that will enable us to say with confidence whether cardiac dysfunction—basically transient or complete heart failure—has played a role in acute events.
We are also looking for evidence of compromised cardiac function in all horses, from those that appear normal and perform well, through those that experience hemorrhage, to those that die suddenly without apparent cause. Our hope is that we can not only identify horses at risk, but also focus further work on the role of the heart as well as the significance of specific mechanisms. And we hope to better understand possible cardiac contributions to EIPH in the process. This will involve digging deeply into some aspects of cellular function in the heart muscle, the myocardium of the horse, as well as studying ECG features that may provide insight and direction.

Fundraising is underway to generate seed money for matching fund proposals, and grant applications are in preparation for specific, targeted investigations.











Our studies complement those being carried out in numerous, different centres around the world and hopefully will fill in further pieces of the puzzle. This is, indeed, a huge jigsaw, but we are proceeding on the basis that you can eat an elephant if you're prepared to process one bite at a time.
How can you help? Funding is an eternal issue. For all the money that is invested in horses there is a surprisingly limited contribution made to research and development— something that is a mainstay of virtually every other industry; and this is an industry.
Look carefully at the opportunities for you to make a contribution to research in your area. Consider supporting studies by making your experience, expertise and horses available for data collection and minimally invasive procedures such as blood sampling.

Connect with the researchers in your area and find out how you can help. Watch your horses closely and contemplate what they might be telling you—it's easy to start believing in ourselves and to stop asking questions. Keep meticulous records of events involving horses in your care—you never know when you may come across something highly significant. And work with researchers (which often includes track practitioners) to make your data available for study.
Remember that veterinarians and university faculty are bound by rules of confidentiality, which means what you tell them should never be ascribed to you or your horses and will only be used without any attribution, anonymously. And when researchers reach out to you to tell you what they have found and to get your reactions, consider actually attending the sessions and participating in the discussion; we can all benefit—especially the ultimate beneficiary which should be the horse. We all have lots to learn from each other, and finding answers to our many challenges is going to have to be a joint venture.
Finally, this article has been written for anybody involved in racing to understand, but covering material such as this for a broad audience is challenging. So, if there are still pieces that you find obscure, reach out for help in interpretation. The answers may be closer than you think!
Her career was short. Perhaps, had we known precisely what was going on, we might have been able to treat her, or at least withdraw her from racing and avoid a death during work with all the associated dangers— especially to the rider and the associated welfare concerns.
Had we had the tools, we might have been able to confirm that whatever the underlying cause, she had cardiac problems and was perhaps predisposed to an early death during work. With all the other studies going on, and knowing the issue was cardiac, we might have been able to target her assessment to identify specific issues known to predispose.
In the future, greater insight and understanding might allow us to breed away from these issues and to better understand how we might accommodate individual variation among horses in our approaches to selection, preparation and competition. There might be a lot of Oysters out there!
For further information about the work being undertaken by the University of Guelph
Contact: Peter W. Physick-Sheard, BVSc, FRCVS. Professor Emeritus, Ontario Veterinary College, University of Guelph. pphysick@uoguelph.ca
Research collaborators:
Dr. Glen Pyle, Professor, Department of Biomedical Sciences, University of Guelph. gpyle@uoguelph.ca
Dr. Amanda Avison, PhD Candidate, Department of Biomedical Sciences, University of Guelph. ajowett@uoguelph.ca
• Caswell, J.I. and Williams K.J. (2015), Respiratory System, In ed. Maxie, M. Grant, 3 vols., 6th edn., Jubb, Kennedy and Palmer’s Pathology of Domestic Animals, 2; London: Elsevier Health Sciences, 490-91.
• Hinchcliff, KW, et al. (2015), Exercise induced pulmonary hemorrhage in horses: American College of Veterinary Internal Medicine consensus statement, J Vet Intern Med, 29 (3), 743-58.
• Rocchigiani, G, et al. (2022), Pulmonary bleeding in racehorses: A gross, histologic, and ultrastructural comparison of exercise-induced pulmonary hemorrhage and exercise-associated fatal pulmonary hemorrhage, Vet Pathol, 16:3009858221117859. doi: 10.1177/03009858221117859. Online ahead of print.
• Manohar, M. and T. E. Goetz (1999), Pulmonary vascular resistance of horses decreases with moderate exercise and remains unchanged as workload is increased to maximal exercise, Equine Vet. J., (Suppl.30), 117-21.
• Vitalie, Faoro (2019), Pulmonary Vascular Reserve and Aerobic Exercise Capacity, in Interventional Pulmonology and Pulmonary Hypertension, Kevin, Forton (ed.), (Rijeka: IntechOpen), Ch. 5, 59-69.
Computed tomography (CT) helps veterinarians make diagnoses and trainers make decisions. CT scanners take hundreds of x-ray images rotating around the target and create an exact 3D digital rendering. The diagnostic power is in the ability to scroll through the 3D rendering slice by slice, at any angle you choose.
• Small stuff: Tiny P1 fractures and early condylar and coffin fractures: scrolling slices one at a time the tiniest cracks, even bone sclerosis patterns that precede cracks, become clearly visible.
• Hard to see spots: Small bones of the knees and hocks, the suspensory origin, non-displaced cracks in the sesamoids: difficult to evaluate properly on radiographs but clear on CT. CT is also far superior for finding and correcting abnormalities of the skull, teeth and sinuses.
• Cartilage: Arthroscopic surgery has typically been required but by injecting the joint with radio-opaque contrast (sometimes called “dye”) we can see cartilage lesions on CT.
• Fracture prognosis: Two simple condylar fractures may have vastly different outcomes based on trauma unnoticed on plain radiographs. CT enables more accurate prognostication critical for planning the horse’s future.

• The neck: It is shocking how many abnormalities are visible with 3-dimensional imaging of the neck. Nerve compression is visible even when it comes from the side; previously undiagnosable with regular radiographs.
• Surgery: CT guidance enables accurate fracture reconstruction and precise placement of screws in difficult locations.
When to use it? Think of CT as a microscope; use it when you know where the problem is, but you just can’t see it on radiographs. If you cannot localize the issue, you probably need a bone scan (scintigraphy).

Image quality and a standing horse.
Two main types of CT: cone beam (x-ray beam is a cone, producing image distortion) and fan beam (beam is a thin blade).
Image detail is far superior with fan beam; the main reason MidAtlantic Equine moved to it from the robotic CT. Most fan beam CT units are small and require general anesthesia. The CT scanner at Mid-Atlantic Equine is a Canon large bore CT mounted on a computer controlled platform, allowing true CT imaging in a standing horse (foot to forearm or gaskin, nose to base of the neck C5/6 or 6/7). Under anesthesia imaging of elbows, shoulders, chest, thoracic spine, back, pelvis, SI, hips and stifles can be obtained.
We every type of medical care your four-legged athlete could ever need. With board-certified specialists in all fields we provide everything from upper airway, arthroscopic and laparoscopic surgeries, to internal medicine, complex fracture fixation and advanced diagnostic imaging, including bone scans, CT scans, and MRIs — all in one place. It’s to make a human jealous.
We offer every type of medical care your four-legged athlete could ever need. With board-certified specialists in all fields we provide everything from upper airway, arthroscopic and laparoscopic surgeries, to internal medicine, complex fracture fixation and advanced diagnostic imaging, including bone scans and MRIs — all in one place. It’s enough to make a human jealous.
800.724.5358
40 Frontage Road Ringoes, NJ 08551 www.midatlanticequine.com

Now imagine—with just over 150 career starts as an owner of 14 Thoroughbreds—that horse was the last one you own after 50 years of loving, working with and racing horses.
Like every other owner, 75-year-old Tom Egan was told never to fall in love with his horses. He couldn’t help himself with Red Knight, a remarkable eight-year-old gelding who returned from an 11-month layoff to capture the $156,000 Colonial Cup at Colonial Downs and the $694,180 Gr. 2 Kentucky Turf Cup Stakes at Kentucky Downs by a nose.
“Red is my last horse,” Egan said. “I’m very close to him.”
He just wishes his wife Jaye, who died December 30, 2016, at the age of 53 after a brave, 17-year battle with breast cancer, was with him to enjoy Red Knight’s success. “Racing isn’t the same without her. Marriage isn’t the same. We accomplished so much more than we could have hoped. My wife was such a beautiful person. Shared joy is better than joy.”
They met in July 1990. “I took her, with much trepidation, to Saratoga,” he said. “I thought, ‘Is she going to like it? What if she thinks it’s silly?’”
She thought it was wonderful. “Man, she loved it, she wanted to get there before the first race and stay until after the ninth.”
Egan’s interest in Thoroughbreds traces back to his father, Lester, an attorney in Hartford, Connecticut, who loved gambling and horse racing. “My dad was primarily a tax attorney; to me, it was too boring.”

Egan, who now lives in Ocala, also became an attorney after attending the University of Hartford and Quinnipiac Law School. “I did personal injury, criminal law and eminent domain.”
Asked if he enjoyed it, Egan said, “There were only two things wrong with the practice of law: judges and clients.”
Mostly retired now, he said he’s a “recovering attorney.” A couple of long-time clients still use his services.
Egan’s first visit to a racetrack came in 1971 at Rockingham. He then attended Suffolk Downs before visiting Saratoga and Belmont Park. In 1976, he took a job working as a hot-walker and groom at a farm in Massachusetts, then with John Russell, who was training for the powerful Phipps Stable.
But he didn’t stick to racing, attending law school and beginning a career.
Winning a stakes race, let alone a graded stakes, is a thrill for any Thoroughbred owner. But what if you also bred that horse? That’s special—literally choosing the mating, then deciding to keep him rather than sell him at auction, and waiting a year or two to race him.LEFT: Tom Egan with trainer Mike Maker and jockey Gerardo Corrales before Red Knight’s run in the Gr. 3 Sycamore Stakes at Keeneland, October 2022.
His first horse was a pleasure horse, Rebel, in 1970. “I rode him on weekends. He did what I wanted him to do: run fast and true.”
Egan’s first Thoroughbred was Shadow, a grandson of Forward Pass. Egan began riding jumpers with him. “I got up to 3-foot-3. Shadow could jump 4-9.”
More than 30 years later, with the love of his life in hand, he plunged into Thoroughbred ownership—modestly. He decided to race and breed under the name of Trinity Stable, even though there is no stable nor farm. The 250-year-old Trinity Church behind his house was his inspiration.
In 2003, the Egans purchased the dam Isabel Away, a daughter of Horse of the Year Skip Away, at the Keeneland Sale, for $60,000. “My wife saw the mare and said that we just had to have her. I think the first thing she liked was her color, but upon closer examination, she really liked her an awful lot. When I saw her in the back walking ring before she went out to the sales ring, she was just very classy and composed. At that point, I said, ‘Yeah, sounds good.’”
Though she won just one of 11 lifetime starts, she would produce two New York-bred geldings who have combined to win more than $1.8 million. And Red Knight isn’t done racing.
The following April, the Egans were at Keeneland for the spring meet. “We met a trainer, and he said, ‘Ninety-five percent of owners get involved because of status.’ My wife calmly looked at him and said, ‘We’ve been here three days. We had no seats; we don’t know anybody, and we’ve had a lovely time.’”
Ten years later, the older of the two brothers, Macagone (pronounced Ma-ka-gon), a speedy son of Artie Schiller, took the Egans on quite a run. After being claimed away from the Egans for $40,000 on June 27, 2018, Macagone continued racing until the age of nine, finishing with 11 victories, six seconds and eight thirds from 47 starts with earnings of $654,981.



Identifying Macagone was easier than pronouncing his name correctly. “Tom Durkin, the greatest race caller ever, even got it wrong. I had a couple of friends talk to him about the pronunciation. He couldn’t get it. I was in downtown Saratoga at an Italian designer’s shop one morning and I was admiring one sports jacket. The owner of the store said he had made it for Tom Durkin, and he was picking it up the next morning. I put a note in his jacket with the horse’s name. Tom pronounced it correctly every time after that.”

Graduates of the New York breeding program have set world records, gar nered multiple Classic and Breeders’ Cup victories, won more than 80 Grade I races and include more than 60 millionaires NY bred GSWs in ‘22 include SPENDARELLA (G1), RED KNIGHT (G2, millionaire), UN OJO (NY sired G2 KY Derby prep winner) & SOMELIKEITHOTBROWN (NY sired G3SW in ’22, G2 millionaire), as well as NY sired KEEPMEINMIND (G1PL in ‘22, G2SW of $900k)
W ith richer purses in 2022, breeder awards are reaching all time highs. More than 800 races for NY breds in 2022 including 60+ restricted stakes, $85K MdSpWts, $95K races for non winners of 2/$45K CLM and the NY Stallion Stakes Series worth $2 3 million, including $500K races for NY sired 2 year olds foaled anywhere
In 2021, NY bred yearlings at auction brought a higher average ($62,776 from 531 sold) than yearlings foaled in any state outside KY (*more than 10 sold) At the 2021 Keeneland November Breeding Stock Sale, NY bred weanlings topped the weanling sale average at $70,491, as well at the median at $47,500.
The incentives offered by the New York Thoroughbred Breeding & Developement Fund are among the richest in the country, attracting such renowned breeders as Chester and Mary Broman, Michael Dubb, Gainesway Thoroughbreds, Ltd , Godolphin, Fred W Hertrich III, Klaravich Stables, Newtown Anner Stud, Repole Stable, SF Bloodstock and Barry K Schwartz to breed in the Empire State Plus, the new rule regarding non resident mares purchased for more than $50,000 at auction makes it easier than ever bef ore to foal a registered NY bred.
For more information about making your next foal a registered NY bred, visit our website or call 518.388.0174.

Egan called Macagone “...a cool horse; he reminded me of Sonny Liston in the paddock—a bay with no white markings. He had that look about him: ‘I’m here, I know what I’m doing, and I’m going to kick your ass.’ He beat some very good horses.”
For the Egans, Macagone captured the stakes named for his sire, the Artie Schiller at Aqueduct, by three-quarters of a length at 34-1. Announcer John Imbriale made the call, “A son of Artie Schiller wins the Artie Schiller at 34-1!” Macagone also won consecutive runnings of the Danger’s Hour Stakes at Aqueduct before finishing third in it. After he was claimed, Macagone set a then track record at Saratoga, winning a one-mile New York-bred allowance in 1:33.13 on the Inner Turf Course.
Red Knight, a son of Pure Prize trained originally by Hall of Famer Bill Mott, put together a successful career in his first four years of racing, taking the 2020 Gr. 3 Sycamore at Keeneland and finishing second by a half-length a month later in the Gr. 3 Red Smith Handicap at Aqueduct.

Egan, acting on a tip from a friend, found out Red Knight loved raw, sliced sweet potatoes. “They’re palatable to the stomach of a horse,” Tom said. “A friend of mine suggested it.”
At the age of seven last year, Red Knight finished second in the Gr. 3 Louisville at Churchill Downs but didn’t hit the board in five other starts.
Egan decided to give him a long break and switch trainers. “It took him 11 months to get healthy,” Tom said. “I called Mike Maker. I said, ‘You don’t know me, but you might know my horse, Red Knight.’ He said, ‘Oh, yes I do.’”
Maker has obviously done a splendid job with Red Knight, who in two starts has made 2022 Tom’s highest single-season in earnings. Red Knight’s success gave Egan a problem, a good problem to have: should he supplement Red Knight to the Gr. 1 $4 million Breeders’ Cup Turf for $100,000?
“I’m never going to have that problem again,” Egan said.
Either way, Egan has already been working with his good friend, Laura Fonde, a hunter-jumper rider, to transition Red Knight to a successful and meaningful second career. “He’s never going to be happy just standing out there in a field.”

He knows his horse, who has 10 victories, eight seconds and one third from 29 starts with earnings of more than $1.2 million. Earlier this year, he knew his horse wasn’t done racing at its highest level. If not, he would have retired him. “I could tell that he still had it in him.”
Tom Egan knew. Maybe Jaye Egan did too.






Annie Lambert Dr. Michael Manno, GaloppFoto.de, Pam MacKenzie Photos
Even though the sacroiliac joint (SI) was on veterinary radars long ago, due to its location buried under layers of muscle in the equine pelvic region, the joint and surrounding ligaments were tough to diagnose and treat.
The sacroiliac joint is often a source of lower back discomfort in race and performance horses. Trainers may notice several clinical signs of a problem. These hints include sensitivity to grooming, objections to riders getting legged up, stiffness of motion, pain to manual palpation of the rump or back, resistance to being shod behind and poor performance.

Of course, those symptoms could describe other hind limb soundness issues, making the origin of the problem arduous to ascertain. A thorough physical examination with complete therapeutic options can relieve sacroiliac pain. The treatments are complicated, however, by the anatomy of the SI area.
The equine pelvis is composed of three fused bones: ilium, ischium and pubis. The sacrum, the lower part of the equine back, is composed of five fused vertebrae. The sacroiliac joint is located where the sacrum passes under the top of the pelvis (tubera sacrale). The dorsal, ventral and interosseous sacroiliac ligaments help strengthen the SI joint.
The SI and surrounding ligaments provide support during weight bearing, helping to transfer propulsive forces of the hind limbs to the vertebral column — creating motion much like the thrust needed to break from the starting gate.
Sound complicated? It certainly can be.


It wasn’t until modern medical technology advanced that the SI could be explored seriously as a cause of hind lameness.
“The sacroiliac is one of the areas that’s very hard to diagnose or image,” explained Dr. Michael Manno, a senior partner of San Dieguito Equine Group in San Marcos, California. “[Diagnostics] of the area probably correlated with bone scans or nuclear scintigraphy. You can’t really use radiographs because the horse is so massive and there is so much muscle, you can’t get a good image.
“About the only time you can focus on the pelvis and get a decent radiograph is if the horse is anesthetized— you have a big [x-ray] machine and could lay the horse down. But, it’s hard because with anything close to a pelvic injury, the last thing you want to do is lay them down and have them have to get back up.”
The nuclear scintigraphs give a good image of hip, pelvis and other anatomical structures buried deep in the equine body, according to Manno, a racetrack practitioner. “Those images can show areas of inflammation that could pretty much be linked right to the SI joint.”
The other modern technological workhorse in the veterinary toolbox is the digital ultrasound machine. Manno pointed out that veterinarians improved diagnostics as they improved their ultrasounding skills and used those skills to ultrasound areas of the body they never thought about before. Using different techniques, frequencies and various heads on the machine’s probe, the results can be fairly remarkable.
“The ultrasound showed you could really image deeper areas of the body, including an image of the sacroiliac joint,” Manno said. “It can also show some ligament issues.”
THE SACROILIAC IS ONE OF THE AREAS THAT’S VERY HARD TO DIAGNOSE OR IMAGE.”
Horses that present as sore in the hindquarters can be perplexing to diagnose. Sometimes the problem is found in the last place you look – the sacroiliac joint.



Where the SI is buried under the highest point of a horse’s rump, and under heavy gluteal muscles, there are two sets of ligaments that may sustain damage and cause pain. The dorsal sacroiliac ligaments do not affect the sacroiliac joint directly, but help secure the ilium to the sacral spine. The ventral sacroiliac ligaments lie deeper, in the sacroiliac joint area, which they help stabilize. These hold the pelvis tight against its spine. The joint itself, being well secured by these ligaments, has little independent movement and therefore contains only minimal joint fluid.

Diagnosing the SI can be complex because horses often travel their normal gait with no change from normal motion—no signs of soreness. Other horses, however, are sore on one leg or another to varying degrees, sometimes with a perceptible limp.
“I don’t know that there is a specific motion,” Manno explained. “You just know that you have a hind end lameness, and I think a lot of performance horses have mildly affected SI joints.

“The horses that are really severe become acutely lame behind, very distinct. You go through the basic diagnostics, and I think most of these horses will show you similar signs as other issues behind. We palpate along the muscles on either side of their spine and they are sore, or you palpate over their croup and you can get them to drop down—that kind of thing. Other times you do an upper limb flexion on them and they might travel weird on the opposite leg. So, it can be a little confusing.”
In the years prior to the early 2000s, the anatomical location of the SI hindered a definite diagnosis; decisions on hind soreness were more of a shrug, “time and rest” treatment evaluation. As one old-time practitioner called it, a SWAG – “Scientific Wild Ass Guess.”
Even with modern tools, making a conclusive diagnosis can be opaque.
“The less affected horses, through exercise and with medications like Robaxin [muscle relaxer] or mild anti-inflammatories, seem to be able to continue to perform,” Manno said. “I don’t know how you can be perfectly sure of an inside joint unless you try to treat it and get results.”

Ilium
Lumbar Vertebrae Sacroiliac Joint
Sacral (Pelvic) Vertebrae Tuber Sacrale Tuber Coxae Ischium
DIAGNOSING THE SI CAN BE COMPLEX BECAUSE HORSES OFTEN TRAVEL THEIR NORMAL GAIT WITH NO CHANGE FROM NORMAL MOTION –NO SIGNS OF SORENESS.”Dr. Michael Manno

“That’s why bone scans came into play and are really helpful,” Manno added. “You can image that [SI] area from different angles with the machine right over the path of the pelvis, looking down on it or an angle view into it, and then you see it from the side and the back very often. We can get an idea from the different views and angles of where the inflammation is and pinpoint the problem from that.”
Once Manno has a generalized idea of where the problem is, he fine-tunes his hypothesis using more diagnostics with a digital ultrasound machine.
“You can ultrasound from up above and see the joint that way,” he said. “As ultrasound has progressed, we’ve found that the rectal probes the breeding vets have used can also be tuned in to start looking for other things. If you turn them upwards, you can look at the bottom of the pelvis and the SI joint. You can see things through the rectum by just looking straight up. That is a whole new thing that we probably never thought about doing. I don’t profess to be very great at it, it’s not something I do a lot, but there are people that are just wonderful at it.”
But, if the diagnosis is incorrect, the prescribed treatment may be anything but helpful.
“In many cases, if a horse is really sore, you need to be very careful,” cautioned Manno. “What you don’t want to do is go from a strain or some sort of soft tissue injury into a pelvic fracture by trying to keep them going. In many cases you are back in the old rest and time type of treatment.”
Manno pointed out one treatment that has advanced over
many years is injecting the SI joint directly. There are a couple of techniques used when injecting the SI. With a blind injection the practitioner directs a long, straight needle into the joint by relying solely on equine anatomy. The other technique employs an ultrasound machine to guide the placement of the needle into the joint.
“Normally we are just injecting cortisone in those cases,” Manno noted. “We are trying to get the inflammatory response to settle down. Hopefully that gives the horse some relief so that they’re a bit more relaxed in their musculature. You know how it is when you get a sore back—it’s hard to keep yourself from cramping, which makes everything worse.”
A slight tweak of that technique is to use a curved needle. When you are positioning the curved needle, it follows the curve of the horse’s anatomy and helps the practitioner direct the injection into the joint.

“It curves right into position for you—it gives you a little help,” Manno confirmed of the curved needle. “Some people are really good with that technique; others still like to go to the straight needle. [The curved needle] helps you approach the site without interference from the bones in that area.”
SI joint injuries affect most performance horses, including Standardbred trotters and pacers, Western performance athletes as well as hunters, jumpers and dressage horses.


The older show horses are often diagnosed with chronic SI pain, sometimes complicated by arthritis. These chronic cases— and admittedly some racehorses—are treated with different therapies. These conservative, nonsurgical treatments have been proven effective.

Slightly rounder front shape than the
or Legendary
Front and Hind pattern


narrower front pattern and heel width
a more traditional shoeing style
prevent shoes from sliding back
thicker material that provides good strength and wear






used for horses with a “long toe”







wider outside heel making this a left and right shoe
side clips
In addition to stall rest and anti-inflammatories, physical training programs can be useful in tightening the equine patient’s core and developing the topline muscles toward warding off SI pain. Manno, a polo player who also treats polo ponies, believes the hard-working ponies avoid having many SI injuries due to their fitness levels.
“I think these polo horses are similar to a cross between a racehorse and a cutting horse,” Manno opined. “They are running distances and slide stopping and turning.”
Other treatments utilized include shockwave, chiropractic, acupuncture, therapeutic laser and pulsed electromagnetic therapy.
With the new diagnostic tools and advanced protocols in their use, veterinarians can pinpoint the SI joint and surrounding areas much closer. This gives them an improved indication that there definitely is an issue with the sacroiliac.

When there is a question about what is causing hind end lameness, most practitioners begin with blocking from the ground up.
“In many cases with hind end lameness that we can’t figure out, we block the lower leg; if it doesn’t block out down low, we conclude the problem is up high,” Manno said. “Once you get up to the hock you’re out of options of what you can figure out. You start shooting some x-rays, but by the time you get to the stifle, you’re limited. Bone scans and ultrasounds have certainly helped us with diagnosing.”
Manno doesn’t see a lot of SI joint injuries in his practice, but he noted there were cases every now and again. He also opined that there were probably other cases that come up in racehorses on a short-term basis. He also noted that, although it may not be a real prominent injury, that’s not to say it has not gone undiagnosed.
“I think we realize, in many of the horses we treat, that the SI joint is something that may have been overlooked in the past,” Manno concluded. “We just didn’t have the ability to get any firm diagnosis in that area.”

I THINK WE REALIZE, IN MANY OF THE HORSES WE TREAT, THAT THE SI JOINT IS SOMETHING THAT MAY HAVE BEEN OVERLOOKED IN THE PAST. WE JUST DIDN’T HAVE THE ABILITY TO GET ANY FIRM DIAGNOSIS IN THAT AREA.”ABOVE: Other treatments utilized to ward off SI pain include shockwave, chiropractic, acupuncture, therapeutic laser and pulsed electromagnetic therapy.

A horse’s every move is a

of
the

can
in
Going to the track with your father is a powerful experience for a little boy—a treasured memory. “I grew up on the Jersey shore, and my dad used to take me out to Monmouth Park,” Dr. Robert Vukovich of WellSpring Stables said. “I was probably nine or 10. He taught me how to read the Racing Form, and sometimes he would place a bet for me. I’ve always loved horses and horse people. I decided if I ever had the chance, I would try to get involved somehow.”
Seven decades later, he is involved up to his gills and wouldn’t want it any other way. The fact that he can share it with his wife Laura makes it even more special. “She’s been there every step of the way,” he said.
Why did he wait until the 1990s to get involved in Thoroughbred racing? “College and my pharmaceutical career got in the way,” he joked. “I started in pharmaceutical research.” He eventually developed his own company, Robert’s Pharmaceutical, and sold it to a large United Kingdom company in the late 1990s. That allowed him to return to horses.

Asked if he ever misses his pharmaceutical career, Robert said, “No. I don’t miss all the pressures. I don’t miss all the deadlines and the regulatory commissions.”
That didn’t prevent him from being successful in his industry. “He came from nothing and has worked very hard,” Laura, a native of Brooklyn with no prior history with horses, said. “We both did. He’s just a warm, caring person even to his horses. He says, ‘You only go around once—no rehearsal.’”
He’s never been happier than he is now with horses. “I wake up in the morning, and I think of horses,” he said. “I talk to people all day about horses, and sometimes I even dream about them— horses like Leave No Trace. Could this be really happening? Did we win the Spinaway?” They did.
In 1999, the Vokoviches bought a horse farm in Colts Neck, New Jersey, where they now also live. “We started with 100 acres and added pieces,” Robert said. “We currently have 168 acres. Laura names most of our horses.”
She named their two-year-old filly star Leave No Trace after a movie she watched some time ago. “I didn’t see the whole movie,” she said. “It was about a father and a daughter and some tragedy.”
Their horse operation has been the complete opposite. They began breeding horses and then started buying them at auctions and racing them. “Over time, I got to appreciate that I could do better than breeding by carefully selecting horses at auctions,” Robert said. “We now buy most of our bloodstock.”
His initial success came with the help of late trainer Dominick Galluscio, who saddled Organizer and Dr. Vee’s Magic to consecutive victories in the rich Empire Classic for New York-breds in 2006 and 2007. “He was a great trainer and a friend,” Robert said.

Now he uses Phil Serpe and Jim Ryerson as his trainers. “After Dominick passed, I asked Jim Ryerson if he’d take a few horses,” Robert said. “He did. I asked him who would be useful to me as a
trainer who races in New York and Florida, and he nominated Phil Serpe. Phil and I have been doing business for seven years. We train our horses in the winter down in Florida and bring them up in the springtime and decide whether to send them to Jim or Phil.”
Robert and Laura now have 15 horses in training, including eight yearlings and five weanlings. They have never done better than the last two years. In 2021, Safe Conduct won the Queen’s Plate. Unfortunately, Robert and Laura weren’t there at Woodbine.
I WAKE UP IN THE MORNING, AND I THINK OF HORSES. I TALK TO PEOPLE ALL DAY ABOUT HORSES, AND SOMETIMES I EVEN DREAM ABOUT THEM—HORSES LIKE LEAVE NO TRACE. COULD THIS BE REALLY HAPPENING? DID WE WIN THE SPINAWAY?”
“We couldn’t get up there to watch in because of Covid,” Robert said. “We had a bunch of people here. When he crossed the finish line, I was stunned. I couldn’t believe it. It was remarkable.” More recently he finished second in the Gr. 3 Monmouth Stakes. “He’s still a special horse,” Robert said.



So is Leave No Trace, who followed a 2 ¼ length debut in a restricted maiden debut at Saratoga by capturing the Gr. 1 Spinaway there at 14-1. Serpe trains both Safe Conduct and Leave No Trace. Robert and Laura purchased Safe Conduct for $45,000 as a yearling at the Keeneland November Sale and Leave No Trace for $40,000 as a yearling at the Fasig-Tipton Mid-Atlantic Fall Sale. Combined, they have earned more than $900,000 with a lot of racing still ahead of them.
But, again, Robert and Laura weren’t at the track when Leave No Trace won the Spinaway. “We were in Switzerland when she won the Spinaway,” Laura said. “We watched it on the telephone. It was around midnight. My husband went bananas. We were very proud.
Now Phil is asking us not to be there in her future races. He said he’d buy us cruise tickets.”
Regardless, Robert and Laura are embracing the ride. “To see a little baby grow up and become a rockstar in horse racing, it’s very fulfilling.” Robert said.
Actually, they enjoy every horse they have, regardless of their performances. “Horses are very honest,” Robert said. “They’re the best employees you can have. They just give you all they have, and they never question it. Mother Nature created these animals so beautiful, so powerful and, for most cases, very gentle around you. You sit and watch them in awe. They always give you their best. They give you everything they’ve got. You can’t ask for more. I’m going to be 80. The horses keep me young.”
HORSES ARE VERY HONEST. THEY’RE THE BEST EMPLOYEES YOU CAN HAVE. THEY JUST GIVE YOU ALL THEY HAVE, AND THEY NEVER QUESTION IT.”
























Just like Dr. Robert Vukovich, noted Thoroughbred bloodstock agent Donato Lanni cherished trips to the racetrack with his father, Giuseppe, who grew up in Italy and settled in Montreal, making a career as a construction contractor. He did well enough to pursue his passion. “My dad had a love and a desire for horses and horse racing,” Donato said. “He had some claiming horses.”
They were harness horses and Donato and his father shared evenings at Blue Bonnets Racetrack. “I grew up around it,” Donato said. ”As a kid, there’s something inside you that gets alerted. You catch the bug. I don’t think that’s a myth. I was eight or nine.
“Summertime, I got more involved. I spent all my time at Blue Bonnets going to the barn. I became a groom when I was 13 or 14. There I got to meet some really cool guys—some of the most legendary guys in harness racing: Andre LaChance, Sylvan Filion and Duncan MacTavish. Andre never talked and was not very pleasant to be around, but he was a hell of a horseman. He took a liking to me for some reason. I drove in qualifier (non-betting) races.” Donato was 16 when he bought his first horse.
Though Donato graduated from Concordia University in Montreal, he realized that he wanted to head south—far south. Taking advantage of a summer program at Concordia, Donato got a temporary visa to work in the United States, fixating on Kentucky.
“I didn’t see a future in Canada,” he said. “I asked, ‘How am I going to make a living with horses?’ I thought I had to go to Kentucky and see what it was like. I left Canada, knowing I was never going back.”
But he had no connections in America. “You take a chance and go to work,” Donato said.
And when you can’t find work? Running out of money, Donato bought a tent and camped out at the Kentucky Horse Park.
He got a huge break when he met John Cashman of Castleton Farm, one of the premier harness farms in North America. “I got a job with John,” Donato said. “He was very nice to me. I became the yearling manager in 1996. I was 25. I kept working. Grind, grind. Eventually doors open and you meet people.”

He counts himself lucky for meeting and then working for John “Big Johnny” Jones, the founder of Walmac International Farm in Lexington, where such super stallions as Nureyev and Alleged stood. Jones was also the founding partner of Four Star Sales. Initially, Donato landed a job with Walmac selling stallion services.
“If there was one person most responsible for any success that I had, it was Johnny Jones,” Donato told Murray Brown in his October 2021 story in Harness Racing Update. “Johnny was a noted bloodstock agent who ran Walmac International. It was from him that I learned my craft. He sold and bought horses. Eventually, so did I. While I was at Walmac, Johnny supported me on my first route towards becoming an American citizen.”
While with Walmac, Donato got to know Thoroughbred owner and movie theater magnate George Krikorian. He told Donato to let him know if one yearling caught his eye at any of the sales. One did—Starrer. She sold for $35,000 and won multiple Gr. 1 stakes on the way to becoming Donato’s first millionaire. In an article in Blood-Horse magazine, Krikorian said of Donato, “I don’t know anyone who had a better eye for horses than he does.”
Eventually, Donato worked for John Sikura’s Hill ‘n’ Dale Farm as director of Bloodstock Services, and became friends with Hall of Fame trainer Bob Baffert. “I met Bob 20 years ago at a sales,” Donato said. “He took me around and showed me what to look for. We’re still pretty close. I learned my craft through Bob Baffert. He’s a great horseman. He’s the best.”


Donato has paid Baffert back by selecting two Horses of the Year: Arrogate (2016) and Authentic (2020).
In 2006, Donato reconnected with Canadian horsemen, specifically trainer Kevin Attard. Attard trained Leonnatus Anteas, a yearling colt Donato picked out for Nob Hill Farm. The following year, Leonnatus Anteas won all three of his starts and was named Canadian Champion Two-Year-Old Colt. “That was the start of our relationship together,” Kevin said. “He sent me a couple horses over the years. For me to be associated with him has been a boost to my career. He respects me as a trainer.”
A few years back, Donato decided to start a new team. He convinced several Canadian horse owners and hockey fans to form X-Men Racing and then partnered with SF Racing and Madaket Stables. Lanni nicknamed the partnership “The Avengers. We put a fund together and bought a dozen horses,” Donato told Murray Brown in his story. “They’re all guys that are in the horse business—some of them with Standardbreds. But what they all have in common, besides being friends with me, is that they’re all lucky.”
One of the original dozen X-Men Racing horses was Moira. All the filly did in August was defeat colts while taking the $1 million Gr. 1 Queen’s Plate by seven lengths in track-record time. Less than a month later, their two-year-old filly Last Call won the Gr. 1 Natalma.
Through all the ups and downs, all the twists and turns of his colorful career, he never lost that feeling he first experienced when he went to the track with his father. “They’re majestic animals,” Donato said. “They’re beautiful to look at. You go work with them; it’s very challenging and it’s fun. We got started because we love the horse.”

Growing up in Ogden, Utah, Patrick O’Keefe never saw a racetrack. But it didn’t prevent him from falling in love with a horse.
Patrick did bond with his father through railroads. “I’m a two-generation railroad worker,” he said. “My dad worked for the Union Pacific Railroad. I worked there while I was going to college at the University of Utah. Just before I graduated, he had a heart attack and died. My railroad career ended at that point. So I hooked up with a good friend, Dennis Bullock. I loved golf. We went looking for a property to build a golf course. We looked all over the country. We didn’t have a lot of money, but we had a lot of energy.”
Their search took them to Bear Lake, Idaho, near the southeast border of Idaho and Utah, and Patrick liked what he saw. They found the property owner and made a deal. “I gave him $10 down,” Patrick said. “I had to come up with $2,000.”
He did. They built a golf and country club, and then sold some 1,000 lots on the property. “I was pretty good at sales,” Patrick said.
On a fateful day, one of Patrick’s buddies from home, Wayne Call, paid a visit. He’d moved to the east and was back visiting family. “He lived right next to me in Ogden,” Patrick said. “His dad worked for Union Pacific.” Wayne, who had worked in bloodstock and trained a few horses, told Patrick he thought Bear Lake would be a great place to raise Thoroughbreds. Patrick told Wayne he thought it was too cold to raise horses but Wayne told him the cold kills parasites and limits disease. In Ray Paulick’s February 2022, story in the Paulick Report, Patrick said, “We have good water and several hundred acres, so I said I’d give it a try. I was dumb as a post. I had no background in racing whatever.”
So he leaned on Wayne and they took off for a nearby off-track betting facility in Evanston, Wyoming. “Wayne told me to look for a mare that’s won a lot of races that had good breeding,”



LEFT: Patrick O’Keefe leads in Classic Causeway after winning the 2022 Gr. 1 Belmont Derby Invitational Stakes.

Patrick said. He settled on Rita Rucker, a granddaughter of Danzig who’d won 21 races, including four stakes and earned $249,767. Her last start was in a $16,500 claimer, and Patrick got her for $7,500.
Patrick chose Kentucky West Racing—a courtesy to Wayne who once owned a hotel named Frontier West—as a stable name and bred Rita Rucker to Thunder Gulch. Patrick decided to raise the foal on his farm in Bear Lake. “My ranch is 200 acres,” he said. “We fenced a paddock. We had a little manger—a lean-to. When they unloaded Rita Rucker, she was absolutely gorgeous. I couldn’t believe my eyes.”
Rita Rucker foaled a filly. Patrick named her Private World, fitting his farm’s secluded area. “I’d drive up to the ranch two or three times a day,” Patrick said. “She’d see me coming and start to run along the fence line. That was her. She just loved to run.”
One snowy evening, she ran away. “Lots of snow, and I came to watch her one night,” Patrick said. “The fence was broken, and she was gone. My ranch adjoins the National Forest. What happened was an elk got through the fence to go after my feed. I saddled another horse and got a lariat. She was at the top of the mountain. I worked my way up to the top of the mountain. It was snowing. It was amazing. It took me hours to get her.”
But he did. “She was just a yearling,” Patrick said. “I built a barn for her.”
When it was time to find a trainer, a friend recommended Bob Hess, Jr. Hess and Patrick quickly discovered they had a talented two-year-old filly. Private World won her first three starts, a maiden race at Del Mar, an ungraded stakes at Santa Anita and the $100,000 Moccasin Stakes at Hollywood Park.

“I’m offered a million and a half after the race,” Patrick said. He didn’t take long to say ‘no.’ “Let me tell you something, I was in love with that horse,” Patrick said. “I was in love with her from the day she was born. I just figured that this horse was going to be the start of something fantastic.”
Her next race was anything but. In the Gr. 1 Hollywood Starlet, Private World tired to finish last—11th by 20 ¼ lengths. She then finished second in a $96,000 stakes and fourth in an $83,000 stakes. She had posted three victories and one second in six starts and earned $166,058.

She never raced again. “She ran through an iron fence and broke her leg,” Patrick said. “I didn’t have any insurance. I lost her for racing, and I thought we would have to put her down.”
Patrick brought her back to Bear Lake, and she slowly recovered. “I spent months with her,” he said. “I hauled in bale after bale of straw. I slept in the barn with her. I bawled my eyes out for a month. I told her as long as she’s alive, I would stay in the business.”
He meant it, and now, at the age of 80, his business is thriving with a partner, Clarke Cooper. After Private World recovered, Patrick bred her to Giant’s Causeway and was rewarded with the three-year-old speedy colt Classic Causeway, who took Patrick and Clarke on a heck of a Triple Crown ride, capturing the Gr. 3 Sam F. Davis and the Gr. 2 Tampa Bay Derby for trainer Brian Lynch.
After Classic Causeway finished 11th in both the Gr. 1 Florida Derby and the Gr. 1 Kentucky Derby, Patrick and Clarke switched trainers to Kenny McPeek. In his first start for his new trainer, the Gr. 3 Ohio Derby, Classic Causeway fought on the front end before weakening to third.
McPeek thought Classic Causeway would handle turf, and he gave his new horse quite the challenge: the mile-and-a-quarter Gr. 1 Belmont Derby at Belmont Park July 9. Sent off at 26-1 under Julien Leparoux, Classic Causeway went wire-to-wire, winning by three-quarters of a length. Subsequent good races, thirds in the Gr. 1 Saratoga Derby Invitational and the Gr. 3 Jockey Club Derby Invitational, leaves his connections plenty of options in a promising future.
Private World has since foaled a colt and a filly weanling by Justify, and she’s in foal to Maximum Security. “We’re loaded; we’re loaded with potential,” Patrick said. “I didn’t take the money when I needed it. I just wanted to go on this journey and see where it takes us.”
On August 31, the journey took him to a destination he’d never envisioned growing up in Ogden, Utah. He was named the Thoroughbred Owners and Breeders Association September Member of the Month. And he knows who to thank.
Asked what he thinks of when someone says “Private World,” he said, “I think of love.”
I WAS IN LOVE WITH THAT HORSE. I WAS IN LOVE WITH HER FROM THE DAY SHE WAS BORN. I JUST FIGURED THAT THIS HORSE WAS GOING TO BE THE START OF SOMETHING FANTASTIC.”BELOW: Classic Causeway, ridden by Julien Leparoux, upsets at 24-1 to win the 2022 Gr. 1 Belmont Derby Invitational Stakes.















“You’ve come a long way baby” was a slogan for a cigarette brand back in the late ‘60s. And while more and more women trainers are commonplace on racetracks, the problem is they and other females are still addressed as “baby” and far, far worse by male workers…in the early 2020s.
Sexual harassment at racetracks, like practically all workplaces across America, exists. And things far worse than a “honey,” “sweetie,” or yes, “baby” is directed at women by men unfamiliar with them, creating uncomfortableness or offense.
To wit, at one racetrack, female workers living on the backside above the barns generally can’t leave their rooms at night by themselves.
At another racetrack, a female assistant trainer living on the backside had to make sure to lock her tack room door as there were persons, presumably drunk and/or drugged men, pounding on it on many nights.

The locations of the instances above are not important because sexual harassment is everywhere on every racetrack. Extremes like the situations above are seemingly minor forms of harassment, not physically threatening but damaging on another level.
Sandra Washington, a 21-year-old assistant trainer to John Alexander Ortiz, is the tack room survivor. Much to Ortiz’s credit (and were all trainers this thoughtful and generous) he moved Washington into his home with his wife and family for two years. He expressed his reason succinctly: “There are some bad people back here.”
There are bad people everywhere, but the racetrack is an environment with living arrangements and working hours that make for far more dangerous scenarios.
A member of one racetrack chaplaincy, who is female and ministers specifically to female backside workers, said, “I am not allowed to work here when it is dark.” Not surprisingly, the racetrack she serves is where female barn workers also can’t go out when it is dark either.
“Most of them take showers right after they work. They don’t want to be out of their room” she said.
“If they do go out, they make sure to be part of a group,” she added, “but most completely avoid it.”
To say the racetrack is different from other workplace environments is comparing Mother Earth to the moon. Where to begin? The biggest difference is a huge majority of female workers on the racetrack do not leave their place of work for homes elsewhere. As many as 85% of workers live in racetrack dorms or above barns (and also above the horses). Life with male coworkers in some kind of proximity is 24/7.
Demographically, female racetrack workers are overwhelmingly Hispanic. In fact, racing in the U.S. might employ more Hispanics, per capita, than any other industry. If this is not a factor in the degree or number of instances of harassment, it certainly is a factor in how female victims respond to it. (More on this later.)

Add to that an outdoor environment. “Catcalls are a common commodity back here,” according to Washington—something that
will bring you before Human Resources in a hurry in office settings, typically. Lastly, there are cultural and economic issues unique to the racetrack.
Understanding the impact of coming to a foreign country and an environment that can be virtually inescapable is a factor in being preyed upon, according to Karen Jemima Davila. She is a student at Southern Baptist Seminary in Louisville and assistant to Churchill Downs racetrack chaplain, Joseph del Rosario. “It’s just work, work, work. They [Hispanic women] save a little bit for themselves and the rest they send back to their homes. It affects how they do things and how they understand themselves.”
Most do not know what is out-of-bounds as far as treatment from men because they are not integrated into American culture, lifestyle, and, most important, rights. And if they do know what is permissible and what is not, they fear reprisal or job loss if they report harassment.
“I’ll lose my job—that’s the biggest fear. ‘If I come forward, are they going to kick me out and take my license?’” said Eli Hernandez, racetrack chaplain at Santa Anita, Del Mar, and San Luis Rey.

“That’s the problem right there. ‘I keep my mouth shut; I’ll keep my job.”
Social pressures also exist to prevent either coming forward or pursuing a complaint to a conclusion and action by the racetrack against a perpetrator. “The word starts getting around that it’s their fault. ‘You brought this on yourself.‘ ‘You’re easy.’ People start whispering,” said Hernandez.
“That’s a lot of pressure. You’re talking about 25-, 26-, 27-yearolds. All they’re trying to do is make a living and support their families. It’s bad enough they’re away from their families,” said Hernandez.
Another factor is a fear of deportation if they come forward—a fear not grounded in fact. According to Hernandez and others questioned, a Hispanic woman who is an illegal immigrant is regarded as a possible victim of an offense and that only. Nothing
more, nothing less. With representatives at every jurisdiction interviewed for this story, the message was the same: immigration status is not and will not be an issue with a woman lodging a complaint.
Are Hispanic women unaware of immunity from deportation proceedings if they file a complaint for sexual harassment? Lynn McNally of the Nebraska Horsemen’s Benevolent and Protective Association (HBPA) responded, “That’s a good question.”

“Probably more could be done to communicate that there wouldn’t be repercussions in their immigration status because they reported something.”
Racetracks—it is safe to say and to their credit—are not ignoring the issue or standing still on measures to prevent it. Churchill Downs and the racetrack chaplaincy, along with non-profit organizations historically supporting efforts there and the Kentucky HBPA are re-instituting meetings from pre-Covid days to make female workers aware of what is and what isn’t sexual harassment, and what to do if they are harassed.
I’LL LOSE MY JOB— THAT’S THE BIGGEST FEAR. ‘IF I COME FORWARD, ARE THEY GOING TO KICK ME OUT AND TAKE MY LICENSE?’ THAT’S THE PROBLEM RIGHT THERE. ‘I KEEP MY MOUTH SHUT; I’LL KEEP MY JOB.”
Before Covid, Churchill Downs conducted three meetings a year in the on-track chapel there.

“There are always new people, so this has to be ongoing— something that we continually address,” said del Rosario.
“The purpose is to encourage women to not accept that kind of behavior…to speak out, that Churchill Downs Security is not going to tolerate it, and to pass the word to others.“

One initiative that was also pre-Covid was hiring a women’s ministry director—a position now filled by Davila. “That has helped build trust. A woman talking to another woman will make it easier,” said del Rosario.
Nebraska tracks are similar to Churchill Downs in that harassment prevention seems to be a collective effort from various racetrack constituencies.
Both the Nebraska HBPA board members and management at racetracks in the state are at the core of a shift in attitudes of mutual respect, according to McNally. “I think that that gives us a tremendous advantage in moving things forward and having women feel comfortable in the workplace.
“There’s a difference between being internally supportive and actually taking action to prevent behaviors from occurring with employees. Our president, Gerald Wilson, has been extremely vocal about treating all employees respectfully. He’s been very, very proactive and vocal about it.”
Women-to-women relationships, counsel, and guidance are probably the most important keys to prevention on Nebraska racetracks as well, according to Lynne McNally. “We are an all-female staff at the HBPA.”

Hernandez, as well, is mindful of gender in building trust issues in his work in Southern California.
“I always have my wife there,” he said of encounters with female barn workers reporting harassment. “Sometimes they just want to talk to my wife.
THE PURPOSE IS TO ENCOURAGE WOMEN TO NOT ACCEPT THAT KIND OF BEHAVIOR… TO SPEAK OUT, THAT CHURCHILL DOWNS SECURITY IS NOT GOING TO TOLERATE IT, AND TO PASS THE WORD TO OTHERS.”
“‘Who can I trust? Who can I come to where I’m not going to be judged? ‘You’re not going to put me down.’ ‘You’re not going to blame me, but you’re going to listen to me,’” Hernandez said, echoing what he has heard and what he has seen in serving as a chaplain in Southern California.
“I told my wife when we started four years ago, ‘Let’s show people our hearts before we ask them to show us their hearts.’”
Hernandez believes he and his wife have built a foundation where women are less hesitant about coming forward.
Coming forward, however, is only the beginning of a process that often is short-circuited by the victim.
He recalled driving a female racetrack worker to make a report who, on the way, told him she didn’t want to proceed with a report after all. “‘I don’t want to get a bad reputation. I don’t want people to start talking bad about me,’” he recalled her saying in response to why she wouldn’t file a report.
“It will happen. Everybody is going to know. Everybody is going to say she’s a slut, or she’s the one who gave in.”
The number of individuals coming to Hernandez—two female workers last year and three in 2020—would seem to indicate the issue is not a big one, at least at Southern California racetracks. The fact is, the number of harassment offenses unreported is inestimable.
The need expressed by everyone responsible for harassment in the racetrack environment is better communication to female barn workers about their rights and making certain of good resources for protection.

Hernandez is an example, perhaps, of resources and equally important, a thoughtful, careful approach to aiding and supporting a victim. “Our main goal is to build trust by having a safe zone here where people just come here.
“We put out clothes, water, toiletries, shoes, and Pampers every day. We also make breakfast for people who don’t have money.
Perhaps more impactful and important for harassment victims is how he and his wife approach the individual. “Let’s do one ‘stitch’ at a time,” said Hernandez, using a wound analogy to describe both what he sees in harassment victims and the care that he and his wife try to bring to women coming to them. “We won’t try to close up the wound in one day. Let’s talk a little bit today and then tomorrow we’ll visit it again.”
Let’s hope racing will have fewer “wounds” for the Sandra Washingtons of racing and the many, many Hispanic female workers simply trying to make a living for themselves and their families in their home countries.
A living is not always a life.
THE NEED EXPRESSED BY EVERYONE RESPONSIBLE FOR HARASSMENT IN THE RACETRACK ENVIRONMENT IS BETTER COMMUNICATION TO FEMALE BARN WORKERS ABOUT THEIR RIGHTS AND MAKING CERTAIN OF GOOD RESOURCES FOR PROTECTION.”



There is always someone absent from the post-Kentucky Derby press conference presenting the winning owner, trainer, and jockey to the media. If you consider the missing person is the individual closest to the winning horse who spends the most time with them, it doesn’t make sense. It also carves away from reportage a beautiful dimension to horse racing. Absent this year, as is always the case, was the groom. Jerry Dixon, Jr. had work to do: lead Rich Strike to the test barn and then to the horse’s barn for a bath and feed.
Today, four short months later, Dixon is absent from Derby-winning trainer Eric Reed’s barn. He mucks stalls now for trainer David Wilson, Jr. at Belterra Park in Cincinnati, 107 miles northeast of Louisville and Churchill Downs and eons away in terms of racing prestige. The last horse Dixon took to a paddock at the time of writing was for another Belterra trainer in a $5,000 claiming race. The reasons for Dixon’s departure from Reed are undisclosed, private, and depending on whom you ask, likely to be disputed.
It’s the racetrack.
The sport of racing demands resilience to disappointment and occasional heartbreak. Ask Steve Asmussen, maybe the hardest working trainer on the racetrack, who is the all-time leader in wins but winless with 24 Derby starters. The very best trainers like Asmussen see roughly only one out of five of their horses winning. Horses purchased for hundreds of thousands of dollars, and occasionally seven figures, flop as racehorses or worse—suffer an injury. Many never make it to the racetrack at all. As for horse owners, there’s an old joke that you can become a millionaire owning racehorses…if you start out as a billionaire. It’s a tough sport. But it has a soul.
That soul is manifested in people like Jerry Dixon, someone who, in less than half a year, has gone from the highest of highs to, well, Belterra Park.
Whatever may have happened with Jerry, there’s no denying in the opinion of many that he gave Rich Strike all of himself. Lindsy Reed, Eric’s daughter, perhaps overstated it only minimally when she said in the wake of the Derby that “Jerry didn’t let that horse out of his sight” during the two weeks the horse was stabled at Churchill Downs before the big race. Horse and groom adopted the same rest schedule, and Jerry slept on bags of wood shavings with his head in Rich Strike’s stall. He would also lie down in the stall. Waking up was left to Rich Strike who, Dixon said, would drop hay or drip water on him to wake him up.
In all sports, there are relationships between teammates, player and coach, and competitors—the best example being jockeys who are de facto guardians of each other’s lives. But horse racing, all by itself, offers animal and human relationships with discoveries that, if they don’t touch you someplace in your heart, they should. There is a unique bond not duplicated between humans. Grooms and horses develop their own language—a kind of telepathy that no other person shares. A good, if not great, groom like Dixon (and he falls more to the latter of those two adjectives) is the protector, caretaker and “interpreter” for the horse, reading the body, the behavior and most importantly the changes that tell a groom first, and subsequently a trainer and others, how the horse is doing and what might be expected. Dixon did all these things in the crucial two weeks leading up to the astounding triumph of an 80-toone longshot.

Breaking the bond has not been easy for Dixon.
“I think about Rich Strike every day. I go through my phone and look at pictures. I even look at the Derby still.”
Dixon’s pairing with Rich Strike and the relationship that followed was not happenstance but one that was carefully considered and thought through by Eric Reed and others, given the already apparent talent of the horse well before the Derby.

Lindsy Reed introduced Dixon to Rich Strike at her family’s training center after her dad claimed him out of a race at Ellis Park. “’I’m going to leave you and Richie alone,’” Lindsy told Dixon and, without another word, walked off, leaving Dixon befuddled and a tad fearful. He knew of the horse’s potential and his importance to the stable. Whether it was a test for Dixon isn’t known but likely.
“So, he didn’t eat you alive,” Lindsy said when she returned to Dixon and Rich Strike. The horse had stood quietly, allowing Dixon to pet him, prompting her to say, “He likes you.” She said nothing more. That may have been when he won the job of the groom for Rich Strike. Before this introduction, trainer Eric Reed had seen what he called a “soft touch” with horses in Dixon that he felt might suit Rich Strike.
The choice of the relatively young Dixon, 31, who has worked on the racetrack for several trainers (including Shug McGaughey),
proved to be a good one. Horse and groom established a bond that was relaxing to the energetic, if not high-strung, three-year-old.
Dixon laying down in the stall became Rich Strike’s cue to lay down as well.
Some waking hours were not so easy, however.
A few days before the Derby, Dixon needed to jog Rich Strike in front of the state veterinarian as required. “I was trying to jog Rich Strike, and he kind of just wanted to walk. Once I smooched to him a little bit to jog, he wanted to put his two front hooves in my pockets.” Rearing up in protest provided a clear message: “I’d rather not jog—maybe another time.
“I was watching the way he was training every morning. He got better and better every day; that was the biggest indicator [of coming performance]. He would bow his neck every morning while he was going. It didn’t matter if it was the day after we breezed him.” Fast recovery from a prior-day breeze or timed workout seemed to have no effect. It was what impressed Dixon most about Rich Strike before the Derby.
Watching a horse and knowing what you are seeing are two very different things. Dixon knew what he was seeing, and it pointed to everything coming up roses, as in the garland draped over Derby winners. He was confident the horse could at least hit the board in the Derby, and the win was not a total shock. “He loved the racetrack.”
A win belongs first to the horse and jockey and, of course a team—starting with the owner who writes the checks, the trainer, the groom, down to the hotwalker.
As for the post-Derby press conference, Dixon had a job to do, which he had done hundreds of times: get his horse back to the barn after a race. It’s hard to imagine this quiet, extremely polite young man, who liberally sprinkles “sirs” or “ma’ams” in his conversation, seeking or enjoying the spotlight. He was where he wanted to be: with the horse.
There were tears and a lot of them for Dixon in the wake of Rich Strike’s Derby victory.
I THINK ABOUT RICH STRIKE EVERY DAY. I GO THROUGH MY PHONE AND LOOK AT PICTURES. I EVEN LOOK AT THE DERBY STILL.”Jerry and Sonny Leon celebrating Rich Strike’s Kentucky Derby win.
There were tears, too, when the relationship between Dixon and Rich Strike came to an end. Psychologists might say Dixon is going through the stages of grief. Whatever the reason Dixon said, “it’s probably going to take a while to jump back in the stall and feel like I’m doing right for a horse.
“I know I still have the eye for it and the talent for it. It’s all about wanting to do it.”
In the meantime, he bides his time raking out soiled straw from stalls, pushing it in a wheelbarrow to a collection area, and spreading fresh straw. It is menial and mindless, but it keeps Dixon home in Cincinnati with his wife and daughter.

The Triple Crown trail, with its excitement and attention from the media and racing world, was “living the dream,” usually expressed sarcastically but true for Dixon. But it had a downside.



“It’s hard to have a family. You have to be all the way in or not at all,” said Dixon. All is demanded of every racetracker who wants to succeed in racing, from trainer to hotwalker. “My wife and daughter missed the family time they wanted to have with me while I was chasing my dream. Stepping away from grooming has given me downtime with my family.”
The racetrack itself is also family for Dixon. A lady in the racing office at Belterra has talked to him daily, telling him over and over, “’Don’t forget. You’re a part of that horse winning the Kentucky Derby.’


“She’s making sure I’m all right. I know where it’s coming from. It’s not people just being kind.”
History is unerasable no matter what is going on in the present or what may come in the future. Dixon obviously heeds the encouragement of the lady in the Belterra racing office. “He won the biggest race in America. That solidifies his greatness. I’m part of the history with the horse.”
Jerry is a fourth-generation horseman, but he and he alone accomplished something no one in his family ever did or likely ever will do. Forevermore, he will be pointed out to generations of Dixons that follow: that Jerry Junior was a groom for a Derby winner.
On a recent muggy summer morning at Belterra as Jerry mucked stalls and spread new straw, an aged hotwalker passing by stopped to ask if I had ever interviewed a Derby-winning trainer (yes) or jockey (yes). “Have you ever interviewed a Derby-winning groom?” he asked with a smile and a twinkle in his eye, knowing the answer as he pointed to Jerry Dixon, Jr.
Racing, again, has its ups and downs, but the triumphs are permanent.
A Kentucky Derby is what people around the world see. What’s not seen is the day-to-day that gets a Derby starter and all other horses down to the cheapest claimer to the starting gate.
For grooms, days can begin as early as 4:00 a.m. in pitch-black darkness, of course, with bathing horses, tacking them up, and readying them for workouts. In Jerry Dixon Jr.’s case, past roles in various barns included coating legs with medication, then applying bandages or wraps, and sending a horse out under an exercise rider. The process is repeated on a second horse while the first is out on the track. When horses return, they must be bathed, their legs medicated, or simply wrapped again and fed. The merry-go-round of horses going out and coming back in from workouts, and the work needed for each horse, is virtually non-stop through 10:30 or 11 a.m.

The day, however, isn’t over. There’s an afternoon feeding, and on race days, there’s taking a horse to the paddock before a race, getting them back to the barn, bathing and feeding. During racing at Turfway Park just across the Ohio River from Cincinnati, which has night racing, the day begins at 5 a.m. for Dixon and can end as late as 10:45 or 11 p.m., if one of the horses in his care runs in the last race. “I don’t get home till midnight,” he said.
His hours during racing at Belterra are only marginally better. He has to be at the track at 4 a.m. and be there at least through feed time at 5:30 in the afternoon. A horse in the last race of the day means an extra hour at the track.
The job is a tough one and getting tougher all the time as not just most, but all racetracks have a shortage of barn help. The shortages, according to Dixon, are going to mean “somebody is
getting cheated.” Something as obvious as a missing horseshoe can be overlooked in the rapid-fire process of getting horses out for workouts in the morning. “There are so many horses and so few people with a limited amount of time to get things done.”
There are other issues related to an individual trainer’s style and the regard with which they hold grooms. “Sometimes it feels like people look at the grooms as if they’re just workers and not in the aspect of being a part of the organization to have some knowledge to be able to give back to the trainer, the assistant, or whoever. Like I’ve said, we spend more time with the horse than anybody else does. We’ll see something before the trainer will. I’ve been in barns where you don’t see the trainer. It’s more of a phone type of deal.”
It’s not uncommon for grooms to sometimes double as assistant trainers, managing the barn for stables—something Jerry did at Turfway. “If we had horses in, I’d make sure I was in contact with the vet. I’d get the Lasix, or, if we had any problems, make sure we got any medication needed for the horse, take them to the races, cool them out, load them on the trailer, unload them—everything,” he said.
Races were, of course, after a full morning. “I would get there and do the stalls, do the groundwork, get the horses out with the exercise riders—find out how far we would train the horses each day.
Days off are two Sundays a month…maybe.
Dixon credits Eric Reed and his daughter Lindsy; other trainers; Reed’s groom Benito Luna, who now cares for Rich Strike; and members of his own family—his father and uncles he describes as “great horsemen”—for mentoring and helping him in his career.
It is a career that is not over. He plans to take the test for a trainer’s license and hang his own shingle perhaps as early as later this year.



























































I’m all for any track trying to be innovative in the sport. So why the hell not try? Oaklawn has such an overlap with tracks in Kentucky. You have to try something. You can’t keep doing the same thing over and over. Our sport is so reluctant at change. I like it. I don’t think it’s going to change a whole lot, but it may keep some trainers who would ship out.

I think that’s a great idea. Oaklawn doesn’t run 12 months. I think the program is good. People like Asmussen, it won’t help them. But [for] other trainers that are struggling, it’s going to help them stay here. I think it’s going to work. I think it’s going to help people.



If you’re there, if that’s a plan, why not? It’s hard to keep horses. If you’re in the claiming game, trying to replace those horses, it’s different. It sounds good on paper. It wouldn’t be a reason for me to stay there. It doesn’t change my life. If I’m going there, it’s because their purses are very high and it’s a nice track.
Website:






Contact:

EquiGym
for
Usefor
Usefor wounds,incisions,lacerations, barb wirecuts abrasions,topicalinfections, nail wounds,trauma, ropeburns.

Contact: T: (888) 890-0659 www.biozidegel.com
Co ntact: T:
www.biozidegel.com

FPD is considered a leader in bringing groundbreaking products and service to the farrier industry as a wholesale distributor of farrier and equine products. F I N D A N F P D D E A L E R N E A R Y O U farrierproducts com/locations • (800) 468 2879












farrierproducts com/fieldguide facebook com/FarrierProductDistribution youtube com/farrierproducts • instagram com/fpdinc
Contact: Anya Sheckley 189 JohnnyCakeHollowRd. Pine Plains,New York 12567 Tel: 646-872-6843 Fax: 518-398-5143 Email: info@hammertowninsurance.com
 KERCK RACE GO
KERCK RACE GO


I think anything the tracks want to do to keep trainers and horses there is fine with me. But I don’t think that’s going to move the needle. If a guy wants to go somewhere else, it’s not enough to keep them there. But anything the tracks want to do to entice trainers to stay or to come to their tracks is good for the business.
Del Mar started the “ship and win”. Every track is fighting for horses right now. I’m not sure the trainers should get it. Maybe the owners should. There should be an appearance fee. I’ve thought that my whole life. The game is so hard for these owners. That gives them something back—helps pay for their groceries and helps them stay in the game. Purses are the bottom line to me. Purses bring horses. That’s what all trainers look for—owners, too.



You have to try it. I’ve been in this business for a long time. I saw things where I thought tracks wouldn’t last another day, and they did. I think you have to give it a try. If someone else thinks it’s a good idea, all you can do is try.

any incentive is a good idea—to try something different.
horse population has shrunk

So
to the horse
to hold

is

